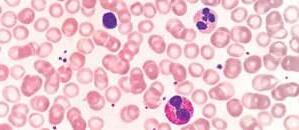

Біологія
УДК 37.016:57:611(075.3)
Б 93
Авторський колектив: Ольга Тагліна, Андрій Самойлов, Ольга Утєвська, Людмила Довгаль
Рекомендовано Міністерством освіти і науки України (наказ Міністерства освіти і науки України від 10.03.2025 № 431)
Видано за рахунок державних коштів. Продаж заборонено
Підручник створено відповідно до модельної навчальної програми «Біологія. 7–9 класи» для закладів загальної середньої освіти (автори Самойлов А. М., Тагліна О. В., Утєвська О. М.)
Б 93
Біологія : підруч. для 8 кл. закл. загал. серед. освіти / [О. В. Тагліна, А. М. Самойлов, О. М. Утєвська, Л. В. Довгаль]. Харків : Вид-во «Ранок», 2025. 256 с. : іл. ISBN 978-617-09-9589-6
УДК 37.016:57:611(075.3)

ISBN 978-617-09-9589-6 Інтерактивний
посиланням rnk.com.ua/107931
Шановні
восьмикласники та восьмикласниці!
Вітаємо вас у світі біологічних наук! Цього
року ви вивчатимете організм людини. І це
дуже важливо! Бо люди не конструктори, які легко полагодити, просто замінивши деталі.
Наші організми складні, багатофункціональні.
Їхні функції просто дивують! Робота серця, кровоносної системи, мозку, нервових клітин… Як багато цікавого! Тож пориньмо в цю надзвичайну науку біологію людини!
Однак організм людини, як і будь-яка жива система, може давати збої. Що відбувається з організмом? Як йому допомогти? Про це ви
зможете дізнатися з нашого підручника.
Щодо структури. Підручник складається з параграфів. Кожен із них починається з рубрики «Поміркуйте й обговоріть ситуацію», а завершується рубриками «Опорні точки» про головне в параграфі, «Запитання і завдання» перевірка вивченого.
Під час роботи в парі або групі не забувайте про взаємооцінювання й самооцінювання. У рубриках «Завдання», «Відкритий мікрофон», «Розв’язання проблемних питань і завдань із теми» та інших ви можете виявити себе, запропонувати власне бачення проблем та шляхи їхнього розв’язання.
Відскануйте QR-код на початку підручника, і ви матимете доступ до електронних ресурсів, насамперед низки інтерактивних завдань. Окрім цього, за спеціальними QR-кодами всередині параграфів ви зможете подивитися навчальні відеоролики, анімації, відеоуроки від провідних
освітян і освітянок України, пограти в мобільні ігри. Ми сподіваємося, що такі



rnk.com.ua/ 109428
є найменшими складниками,
яких побудовані всі живі організми. Водночас клітина теж система, яка складається з органел. Будь-яка клітина це відкрита система, тобто вона здійснює










Мал. 1.1. Мітохондрія

й на мембранах ендоплазматичної сітки. Сполуки, синтезовані в ендоплазматичній сітці, потрапляють до комплексу Гольджі, який їх «сортує», «пакує» й
тіла (епідерміс) і вистилають порожнини тіла (епітелії). Основу епітеліальних тканин формують клітини, щільно з’єднані між собою, водночас міжклітинної речовини тут обмаль. Така будова епітеліальної тканини забезпечує захисну та бар’єрну функції (мал. 1.3). Епітеліальна тканина також виконує й інші функції
в організмі, зокрема, секреторну (залозистий епітелій), всмоктувальну (епітелій кишки), газообмінну (епітелій легеневих пухирців) та ін.
Сполучні тканини є дуже різноманітними:
кісткова тверда, хрящова пружна, кров і лімфа рідкі. Ці тканини мають багато між-
клітинної речовини (мал. 1.4). Сполучні тканини виконують опорні, захисні, трофічні, запасальні, з’єднувальні та багато інших функцій. М’язові тканини забезпечують рух. Вони побудовані зі спеціалізованих клітин міоцитів, які сприймають сигнали від нервової системи й відповідають на нього скороченням. М’язові тканини за особливостями їхнього розташування, будови
групи: непосмуговану
но-посмуговану
(мал. 1.5).
1. Використовуючи постійні мікропрепарати
вчителем або вчителькою зображення, розгляньте
кропрепарати: а) епітеліальної тканини; б) пухкої
щільної сполучної тканини; в) жирової тканини.
2. Замість висновків складіть таблицю, у




Одношаровий війчастий (миготливий)












rnk.com.ua/ 109429

Органи організму людини
Клітини утворюють тканини, які об’єднуються й формують різні органи. Термін «орган» походить від давньогрецького слова «знаряддя» або «інструмент». Саме органи організму тварин і людини є тими «інструментами», завдяки яким відбуваються важливі процеси життєдіяльності. Будь-який орган побудований із декількох тканин. Наприклад, скелетний м’яз і серце сформовані сполучною тканиною та різними типами посмугованої м’язової тканини: скелетної чи серцевої. Стінки кишки складаються зі сполучної, гладенької м’язової та епітеліальної тканин (мал. 2.1, c. 10).
Анатомія — наука, яка вивчає форму й будову організму та окремих органів.
Фізіологічні системи






Антропометрія

травну, дихальну, видільну, кровоносну (серцево-судинну), лімфатичну, імунну, ендокринну, статеву, нервову, сенсорні системи.
Фізіологічна система — це сукупність органів, що спільно забезпечують окремі процеси життєдіяльності,

4.
brain, esophagus, trachea, lungs, heart, stomach, liver, spleen, rectum, spinal cord, kidney.


The musculoskeletal system is an organ system that provides the framework, support, form and movement of the body. The respiratory system is а system that introduces respiratory gases to the organism and performs gas exchange. The digestive system is а system that processes food and extracts nutrients.


Поміркуйте
Ваш шкільний урок триває 45 хвилин. Якщо це не урок фізкультури, то ви в цей час дещо обмежені в рухах.
На перерві хочеться рухатися
активніше. А якщо вас
попросять посидіти 10 хвилин
не рухаючись, це виявиться
непростим завданням.
Чому? Яке значення має
в житті можливість рухатися?
ватися,
спілкуватися, здобувати їжу, будувати житло. Рух окремих клітин здійснюється за допомогою джгутиків, війок і виростів цитоплазми. Перетікання цитоплазми з утворенням псевдоніжок забезпечує амебоїдний рух клітини. Так рухаються не лише амеби, але й, наприклад, лейкоцити людини. Переміщення за допомогою джгутиків і

про способи руху рослин rnk.com.ua/107963
















Склад опорних структур різноманітних організмів
Скелет губок утворений
із кремнезему (силіцій (IV) оксид), або вапняку (кальцій карбонат), або органічних речовин

зміцнені спеціальними білками
Схема 2. Із чого складаються
Скелети коралових поліпів утворені з вапняку (кальцій карбонат)

Кістки хребетних містять гідроксилапатит, до складу якого входить кальцій ортофосфат

має кожна із цих тварин? Наведіть свої приклади тварин із



ніж хорда, що
збільшити розміри тіла. Те, що хребет скла-
дається з окремих хребців, сприяє гнучкості
й активним рухам тварин.
РИБИ. Скелет риб поділяється на хребет, череп, скелет кінцівок (плавців) і їхніх поясів.
У хрящових риб скелет складається з хрящової тканини, а в кісткових риб із хрящової та кісткової.
У риб починається диференціація хребта



жабу, яка вже
може існувати на суходолі.
Які зміни
Як пристосований до життя
на суходолі скелет жаби?
кінцівок. Змінюються пояси кінцівок, які прикріплюють кінцівки до тулуба й забезпечують їхню рухливість.
Скелет поясу передніх кінцівок: парні лопатки, парні ключиці,
(ліктьова й променева), кістки кисті (зап’ястка, п’ястка, фаланги пальців).


велике
кий у земноводних.
ПТАХИ. Скелет птахів
є схожим на



rnk.com.ua/ 109431

функції та особливості
Будова
людини
Опорно-рухова система людини дає
тілу, зумовлює його форму, забезпечує рух, а також
захист внутрішніх органів. Такі її компоненти, як кістки, хрящі, зв’язки, сухожилля та ін., утворені сполучною тканиною.
М’язи складаються з посмугованої м’язової та сполучної тканин. В опорно-руховій системі людини кістки є пасивною, а скелетні м’язи активною частиною, яка забезпечує рухи кісток.
Кістка — це основна структурна одиниця
скелета. Функціями кісток є забезпечення опори, руху

А. Bone D. Ligament
B. Muscle E. Tendon
C. Cartilage F. Articular capsule

1.
2.
3.



має кісткові перекладинки з порожнинами між ними. Саме в порожнинах губчастої речовини кістки розміщений червоний кістковий мозок
кровотворний орган, у якому утворюються клітини крові.
Усередині трубчастих кісток (стегнова, плечова) є великі порожнини, заповнені сполучною тканиною жовтим кістковим мозком, який
містить жирові включення.
Демонстраційне дослідження властивостей кістки
Міжклітинна речовина кісткової тканини складається


Ребра
Груднина
Реберні хрящі
Грудні хребці

Ключиця
Лопатка
кістки
П’ясткові
кістки
Фаланги
пальців кисті



скелета.
складається
хребців, згрупованих у шийний (7 хребців), грудний (12 хребців), поперековий (5 хребців), крижовий (5 хребців) і куприковий (4–5 хребців) відділи. Грудна клітка сформована ребрами (12 пар), грудниною та грудним відділом хребта (мал. 4.3). Скелет поясів кінцівок це кістки, які приєднують вільні кінцівки до скелета тулуба.




(довгі й короткі), які мають тіло й потовщені кінці (променева, кістки п’ястя). Губчасті кістки зверху вкриті тонким шаром компактної речовини, під якою розташована губчаста речовина (ребра). Є кістки, що мають складну форму, різну будову й походження, тому їх
називають змішаними кістками (потилична). Для зменшення маси повітроносні кістки черепа мають порожнину, вистелену слизовою оболонкою й заповнену повітрям (лобова, верхньощелепна).
Особливості
Кістки скелета з’єднуються
спосіб. Є нерухоме з’єднання, за якого кістки міцно зрослися за допомогою сполучної тканини. Є напіврухоме з’єднання,



A joint is a location where two or more bones meet. Joints are classified into three categories. Fibrous joints: bones are joined by dense connective tissue, e.g. sutures — stable unmovable joints of bones of the skull. Cartilaginous joints: bones are joined by cartilages, allowing for some movement, e.g. intervertebral discs and costal cartilages. Synovial joints: bones are not directly joined allowing for free movement. А synovial cavity filled with а synovial fluid serves as a lubricant. The bones in the joint are enclosed by an articular capsule and further stabilized by ligaments. The articular surfaces of bones are covered with synovial cartilage to reduce friction.

Ligament (Зв’язка)
Pelvis (Таз)
Cartilage (Хрящ)
Capsule
Synovial
Femur


Особливості руху людини
Рух одна з основних властивостей живого.
динамічний процес переміщення тіла в
відносно інших тіл або частин тіла одна відносно іншої. Рух забезпечує ходіння, біг, стрибки, підйом вантажів та інші активності людини. Особливістю рухів людини є прямоходіння, яке ще має назву біпедія. Предки людей, які
жили 6–7 млн років тому в Африканській савані, уже пересувалися на двох кінцівках.
Існує кілька гіпотез, що пояснюють розвиток прямоходіння в предків людини:
перехід до життя в саванах (необхідність
спостереження за небезпекою навколо та
швидке пересування);
балансування й економія енергії під час бігу відкритими просторами;
вивільнення передніх
праці











це окремий орган, утворений посмугованою скелетною м’язовою та сполучною тканинами (мал. 5.2). Скелетна м’язова тканина складається з м’язових волокон багатоядерних «клітин» циліндричної форми (мал. 5.3). Усередині м’язових волокон розміщені міофібрили комплекси білків, що забезпечують скорочення. Головними скоротливими білками є актин і міозин. Для скорочення міофібрил, а отже, і м’язів, необхідні катіони Кальцію та енергія молекул АТФ.
М’язові волокна «склеюються» в пучки за допомогою прошарків сполучної тканини.


м’язової тканини
1. Замалюйте будову (мал. 5.3) м’язового волокна та зробіть необхідні підписи.
2. Налаштуйте мікроскоп, розгляньте будову посмугованої м’язової тканини на постійних препаратах або скористайтеся готовими зображеннями.
3. На препараті знайдіть м’язові волокна, ядра та поперечну смугастість.
4. У висновках зазначте назву складників м’язової тканини, їхню форму, кількість ядер, розташування цього типу тканини у вашому організмі.
Прикріплення м’язів М’язи прикріплюються до кісток, уплітаючись у них волокнами


Двоголовий
Згиначі
Косий м’яз
Кравецький м’яз
Чотириголовий
м’яз стегна
Розгинання гомілки


muscle, delts, pecs, biceps, triceps, quads, calf / calves, glutes, abs; flex / bend / unbend.
Серед м’язів нижніх кінцівок найпотужнішими є м’язи, що розгинають нижню кінцівку в суглобах. Вони протидіють силі тяжіння: великий сідничний м’яз, чотириголовий м’яз
стегна та литковий м’яз. До згиначів належить, наприклад, двоголовий м’яз стегна. М’язи стопи здійснюють рухи пальців стопи.
Особливості роботи м’язів Скорочення м’язів потребує енергії, яка витрачається на виконання ними роботи, а решта розсіюється у вигляді тепла. Постачальниками енергії для скорочення м’язів є молекули АТФ. Вони утворюються під час клітинного дихання в мітохондріях. Однак запасів кисню в м’язах і швидкості його надходження з крові вистачає лише на кілька хвилин інтенсивного навантаження. Після зниження рівня кисню м’язи отримують енергію шляхом молочнокислого бродіння глюкози з утворенням молочної кислоти. Так забезпечується тривала робота м’язів за умов нестачі кисню.
Сила м’яза це максимальне напруження, яке він може розвинути. Вона залежить від кількості міофібрил (білків) і м’язових волокон, що припадають на поперечний переріз
м’яза. Виміряти силу м’яза можна за допомогою динамометра або за максимальною масою вантажу, яку він здатен зрушити з місця.
М’язи характеризуються різною швидкістю скорочення повільні або швидкі;
м’яза, який
формою є: веретеноподібним, трикутним, квадратним, ромбоподібним, стрічкоподібним чи коловим; за розміром: довгим, коротким або широким; за функцією: згиначем, розгиначем, відвідним, привідним або обертачем. Які м’язи за функціями є антагоністами («антонімами») чи синергістами («синонімами»)?


можна скористатися формулою роботи A = mgh.
1.
2.
М’язи приводять у рух
частини тіла одна
відносно іншої. Вони
Обов’язкова
Правильна

rnk.com.ua/ 109433

Постава. Порушення постави
Усі ми чули фрази: «Не сутулься!», «Випрями спину!», «Сядь рівненько!». Чого від нас хочуть люди навколо? Взагалі-то нам нагадують про нашу поставу, тобто на ту
у якій ми зазвичай утримуємо своє тіло. У ній усе
важливо: позиція хребта, голови, плечового поясу, рук і ніг.
Постава — це звична поза, у якій людина утримує своє тіло, коли стоїть чи рухається.
Правильною є така постава, яка забезпечує
підтримання природних вигинів хребта, що
уможливлює його амортизаційну функцію. Та-
ких природних вигинів чотири: два вперед шийний і поперековий лордози, два назад грудний і крижовий кіфози. Вони спричинені
прямоходінням.
Правильна постава передбачає, щоб голова та шия були розташовані вертикально,





уперед. Усі ці викривлення хребта є небезпечними, вони
яка
стояти
ходити, утворюється ще один лордоз поперековий. У шість років постава, як правило, уже сформована, але впродовж життя вона здатна змінюватися.
Кіфоз — це викривлення верхнього відділу хребта, яке спрямоване назад.
Лордоз — це вигин хребта, який спрямований опуклістю вперед.
Сколіоз — це бічне викривлення хребта в площині спини.
Що вам допоможе зберігати

природні склепіння
ються або повністю зникають, то під час ходьби, бігу або стояння ноги швидко втомлюються й починають боліти.
Плоскостопість — це деформація природного склепіння стоп, яке стає плоским.
Профілактика плоскостопості передбачає правильний підбір взуття, підтримання нормальної ваги, фізичну активність, уникнення тривалого стояння в одному положенні.
Якщо в людини є плоскостопість, рекомендують виконувати вправи для
стопи та носити зручне взуття на невисоких підборах із супінатором.
Рахіт
Існує
правильного формування скелета, це рахіт. Рахіт є захворюванням, пов’язаним, зокрема, із нестачею вітаміну D. За такої умови
рушується обмін солей Кальцію
страждає нервова система, уражується кісткова тканина, неправильно формується скелет. X Причини розвитку рахіту в дітей:
нестача ультрафіолету, необхідного для синтезу вітаміну D в організмі;




Поділіться своїми думками Розгляньте малюнки. Прочитайте правила надання допомоги при ушкодженнях хребта, травмах черепа та грудної клітки. Поясніть, чому ці правила є саме такими. Чим корисне використання
зв’язки або вивих суглоба. А при пораненнях чи падіннях і сильних ударах можуть статися переломи кісток. При закритому переломі шкіра та м’язи залишаються неушкодженими, а при відкритому переломі відбувається їхнє ушкодження,
Що потрібно для підтримання здоров’я опорно-рухової системи? Докладно про це див. схему 4.
руху та опору.
Ушкодження
Основними симптомами при ушкодженні м’язів є больові відчуття в місцях травми, набряки м’яких тканин, гематоми, почервоніння, синюшність (мал. 6.3; схема 5). Якщо ушкодження є легкими, то для їхнього лікування потрібні стан спокою




Поміркуйте
Філософи всіх часів намагаються пізнати сутність явищ. Спробуйте й ви знайти відповідь, розв’язавши це завдання.
У вас є три предмети: ідеальний термос, пляшки зі щільною кришкою та без неї. В усі ємності додано 100 мл води температурою 80 °С. Що може відбутися в кожному разі з показниками об’єму та температури води? Які спільні та відмінні ознаки в описаних вами явищах?
речовини
Тіло тварин і людини побудовано з клітин і міжклітинної речовини, що містять у своєму складі неорганічні й органічні речовини. Водночас ці речовини побудовані з атомів хімічних елементів, відсотковий вміст (за масою) яких показано на мал. 7.1. З водою та їжею ми отримуємо необхідні неорганічні речовини переважно у вигляді солей. Наприклад, солей

Мал.
катіонів: Na+, K+, Ca2+, Mg2+, Fe2+ — та аніонів: Cl–, HCO3–, HPO42–, SO42–, I–, F– тощо.

Обмін теплом (енергією) Q Q
Мал. 7.3. Відкоркована пляшка з водою — це відкрита система
газ і вода. Частина цієї енергії запасається
ся клітинним диханням (мал. 7.4). Коли молекули АТФ розщеплюються,
С6Н12О6 (глюкоза)
О2 (кисень)
Н2О (вода) Клітина

СО2 (вуглекислий газ)
Мітохондрії (виробляють енергію АТФ для клітини)
Мал. 7.4. Клітина — відкрита система, що здійснює обмін речовин та енергії (на прикладі клітинного дихання)


Анімація «Енергетичний баланс» rnk.com.ua/110372
утворення (синтезу) необхідних організму речовин, які відбуваються з поглинанням енергії.
Катаболізм — сукупність хімічних реакцій розщеплення й окиснення органічних речовин, що йдуть із вивільненням енергії (яка запасається в молекулах АТФ).
Усі хімічні реакції в клітинах організму мають відбуватися швидко. Саме тому необхідні речовини, що їх прискорюють, каталізатори. У клітинах каталізаторами є ферменти білки, що прискорюють хімічні реакції.
Досліджуємо ферменти
1.
Білки
Вітаміни
Вода

отримують усі необхідні для життєдіяльності органічні речовини з компонентами їжі. У клітинах організму ці речовини перетворюються та використовуються як матеріал для побудови
компонентів клітин і міжклітинної речовини. Більша ж частина речовин повністю окиснюється
Завдання
Розгляньте дані щодо вмісту білка в різних продуктах харчування в 200 г продукту: морква — 1,3 г; курка відварена — 25 г; сир кисломолочний — 18 г; тріска — 17 г; кролик — 24 г; буряк столовий — 1,8 г; кальмар — 18 г; огірок — 0,7 г; камбала — 18 г; телятина — 30 г. Проведіть




Мал. 7.5. Енергетичний баланс організму або співвідношення
енергії, що надходить до організму, та енергії,
складає 50 %.
Яку кількість калорій «спалить»
людина, виконавши ці вправи?
Формули, що вам
знадобляться для обчислення: P=A/t, де Р — потужність (Вт), А — робота (Дж), t — час (с).
метіонін та інші), що надходять із білків їжі; есенціальні жирні кислоти (лінолева та ліноленова кислоти), що переважно містяться в рослинних оліях; а також

rnk.com.ua/ 109435

Більшість клітин нашого організму
ся із зовнішнім середовищем. Клітини оточені іншими клітинами та міжклітинною речовиною. Тобто клітини організму живуть у власному «внутрішньому середовищі» (мал. 8.1).
Основою внутрішнього середовища є міжклітинна речовина. Вона складається з органічних сполук (переважно білків і вуглеводів), води та розчинених мінеральних солей. Може бути рідкою (плазма крові), гелеподібною (хрящова тканина) або твердою (кісткова тканина). Завдяки рідині внутрішнього середовища
відбувається транспортування необхідних для кожної клітини поживних речовин, кисню, води й виведення з клітин вуглекислого газу та інших продуктів обміну речовин.
Внутрішнє середовище — це рідини, які оточують клітини організму й створюють умови, необхідні для процесів їхньої життєдіяльності.

Тканинна
Заповнює міжклітинний простір тканин
Утворюється
з рідкої частини
крові та продуктів
життєдіяльності
клітин, фільтрується
в лімфатичні капіляри
та перетворюється
на лімфу
Рідка сполучна тканина, що виконує поживну, видільну, терморегуляторну, регуляторну, захисну функції
Рухається кровоносними судинами і складається з рідкої
міжклітинної речовини (плазми) та формених елементів (еритроцитів, лейкоцитів, тромбоцитів)
Рідка сполучна тканина, яка відповідає за транспортування поживних речовин, знешкодження бактерій, вірусів і токсинів, підтримує гомеостаз Прозора, жовтуватого кольору рідина, яка

внутрішнього
лімфа. Кров, тканинна рідина та лімфа в нашому організмі взаємопов’язані. Крізь стінки капілярів вода та розчинні компоненти плазми крові фільтруються в тканинну рідину. Із тканинної рідини клітини беруть необхідні речовини й виділяють у неї продукти обміну. Сама тканинна рідина фільтрується до лімфатичних капілярів і входить до складу лімфи. Зрештою, лімфатичні судини

Підтримання гомеостазу є критичним для виживання організму. Якщо показники внутрішнього середовища відхиляються від нормальних, то в організмі вмикаються регуляторні
механізми, що нормалізують цей показник. Наприклад, у спекотну погоду, щоб охолодитися, зайве тепло виводиться завдяки розширенню судин шкіри й потовиділенню.
Таблиця 1. Деякі фізико-хімічні параметри внутрішнього середовища людини
Температура тіла 36–37 °С
(кислотність) 7,35–7,45 Артеріальний тиск 120/80 мм рт. ст.

печні наслідки. Так, занадто висока температура тіла призводить до руйнування білків. Якщо ж організм не здатний відновити гомеостаз, розвивається захворювання або стан, що закінчується загибеллю.
Серцево-судинна (кровоносна) система
Серцево-судинна система складається із

Мал. 8.3. Серцево-судинна система


між кров’ю та тканинами. Капіляри збираються у вени. Вени забезпечують повертання крові до серця.
Артеріальна кров — це кров, збагачена киснем. Має яскраво-червоний
складу лімфатичної системи
лімфатичні судини, лімфатичні вузли та лімфоїдні органи (мал. 8.4). Лімфа переміщується лімфатичними судинами, які починаються в тканинах як капіляри, збираються в крупні протоки і впадають у венозну систему. З лімфою транспортуються жири та інші речовини, з нею в кров повертається надлишок тканинної рідини (мал. 8.2, с. 42). Лімфатичні вузли розташовані по ходу лімфатичних судин і містять лімфоцити. Це клітини імунної системи, які реалізують захист від інфекцій (бактерій, вірусів) і чужорідних білків. Лімфоїдні

1.
2.
3.
4.
5.
Unlike blood circulation, which is powered by the heart, the lymphatic system relies on the contraction of skeletal muscles to move lymph fluid. Valves inside the lymphatic vessels ensure that lymph to flows in only one direction.
Longitudinal

Valve
Overlapping
Direction of lymph flow
Valve closed
Fluid



rnk.com.ua/ 109436
у
«Блакитна кров» — говорили колись про людину знатного походження. Холоднокровними називають тих, хто діє без емоцій. Клятва на крові — це непорушна обіцянка.
Наведіть ще такі приклади. Як ви вважаєте, чому ми вживаємо такі слова, коли хочемо сказати щось важливе?


Кров. Плазма крові
Кров це рідка сполучна тканина, яка здійснює транспорт речовин усередині тіла, а також виконує захисну й регуляторну функції. Середній об’єм крові в людини сягає 4–5 літрів, або 6–8 % від маси тіла.
Кров складається з плазми (55 %) та формених елементів (45 %) (мал. 9.1). Плазма крові є рідким транспортним середовищем. Формені елементи крові це клітини крові: еритроцити, лейкоцити та тромбоцити. Усі вони утворюються зі стовбурових клітин червоного кісткового мозку. Головною функцією еритроцитів є транспортування кисню. Тромбоцити забезпечують згортання крові. Лейкоцити відповідають за імунний захист організму.

Поживні речовини (глюкоза, амінокислоти, ліпіди, вітаміни та ін.)
Продукти обміну речовин (білірубін, сечовина та ін.)
Розчинені гази (СО2, О2)
Гормони
Схема 7. Компоненти
Плазма це рідка частина крові (мал. 9.2).
Вона на понад 90 % складається з води, білків та інших речовин (схема 7). Головна функція
плазми крові транспортування поживних речовин, гормонів і виведення
Концентрація розчинених солей у плазмі крові становить близько 0,9 %. Штучний
розчин із такою ж концентрацією
називають фізіологічним
ких втрат крові.
Дослідження
тварин
Проведемо дослідження.
Визначимо, якими є особливості
ментів крові різних організмів;
порівняємо будову еритроцитів крові людини (а) та жаби (б);
визначимо відмінності. Вам знадобляться: мікроскоп, готові мікропрепарати (або їхні
1.
ють транспорт різних речовин (жири, холестерин, йони металів, гормони)
Імуноглобуліни, або антитіла, забезпечують імунітет
Білок фібриноген бере участь
у згортанні крові
Неорганічні йони К+, Na+, Ca2+, Mg2+, Cl , HCO3 , HPO42– є електролітами, підтримують осмотичний і кислотнолужний баланс




Індивідуальна робота
У 1 л крові міститься приблизно 5 млрд еритроцитів. Обчисліть, скільки
має форму двоввігнутого диска (мал. 9.3), що збільшує площу поверхні для газообміну порівняно з кулястою формою. Еритроцити гнучкі, тож можуть протискуватися вузькими капілярами. У людини, як і у всіх ссавців, еритроцити є без’ядерними. Еритроцити заповнені молекулами гемоглобіну білка, який містить гем із катіоном Fe2+, що






Аглютиногени системи
у таблиці 2.
Якщо, наприклад,
ві А (ІІ), то на
аглютиноген А, а в
нін β. Переливання їй донорської крові групи В (еритроцити містять аглютиноген В) призведе до злипання еритроцитів, оскільки аглютині-
ни β плазми реципієнта зв’язують аглютиноген В як чужорідний агент.
Таким чином, для успішного переливання донорська кров має містити такі самі аглютиногени, як і


еритроцитів білка, який називається резус-фактор. Якщо в людини еритроцити мають резус-фактор, то вона резус-позитивна, якщо не мають резус-негативна. Резус-фактор також обов’язково враховується під час переливання крові, бо імунна система резус-негативних людей реагує на резус-позитивну кров як на чужорідну. Запитання
1. Поясніть, як білковий
3.


Лейкоцити
Лейкоцити
які захищають
творних мікроорганізмів, руйнують і
ють ракові клітини, а також чужорідні
(схема 8, с. 52).
Лейкоцити мають ядра, вони різноманітні як за формою, так і за функціями. Усі лейкоцити здатні рухатися за допомогою псевдоніжок подібно до амеб. Вони можуть виходити з кровоносних судин і переміщуватися між клітинами інших тканин. Лейкоцити здатні до фагоцитозу.
Утворюються лейкоцити зі стовбурових клітин червоного кісткового мозку. Тривалість життя становить від кількох годин до десятків років. Зазвичай в 1 мкл крові міститься 4–9 тис.
лейкоцитів. Під час інфекцій і запалень їхній вміст значно зростає (лейкоцитоз). Тромбоцити. Зсідання








Існують захворювання, коли процес зсідання крові порушений. Наприклад, гемофілія зумовлена спадковою нестачею одного з білків факторів зсідання крові. Це рідкісне
захворювання призводить до тяжких кровотеч, що загрожують здоров’ю та життю.
Більш поширеними є стани, за яких кров має підвищену схильність до зсідання. Тромби утворюються, блокуючи нормальний потік крові до органів, навіть якщо судини не ушкоджені (мал. 10.3). У медицині використовують антикоагулянти

1.
2.
3.
4. Розгляньте дані аналізів


rnk.com.ua/ 109438
Як із точки зору фізіології пояснити, чому виникають такі реакції?
які складаються з трьох
(мал. 11.1). Внутрішня оболонка утворена епітеліальними клітинами та сполучною тканиною. Середня оболонка містить еластичні волокна та гладенькі м’язи, які підтримують тонус і діаметр судини. Зовнішня оболонка артерій утворена сполучною тканиною, що зміцнює стінку судини.
судини


Вени забезпечують повернення крові до серця. Їхні стінки складаються з трьох оболонок (мал. 11.1), вони тонкі та еластичні, бо кров’яний тиск у венах маленький.
Кола кровообігу
Кров у нашому тілі циркулює двома колами кровообігу: великим і малим (мал. 11.2). Велике коло кровообігу починається
серця








нізм, що сприяє
стискаються, і кров проштовхується в напрямку серця (мал. 11.3). Руху крові у зворотному напрямку перешкоджають венозні клапани.
Кровообіг в органах і тканинах може змінюватися завдяки тому, що кровоносні судини здатні звужуватися або розширюватися (мал. 11.4). Наприклад, кровопостачання скелетних м’язів

збільшується, коли вони інтенсивно працюють. Звуження та розширення судин відбувається
завдяки скороченню або розслабленню
1. Переконатися у відсутності небезпеки.
2. Провести огляд постраждалого / постраждалої, визначити наявність притомності й дихання.
3. Викликати бригаду екстреної (швидкої) медичної допомоги.
4. Якщо кровотечі немає, слід надіти рукавички; підняти кінцівку; накласти на рану чисту стерильну серветку й бинтову пов’язку.
5. Якщо кровотеча артеріальна, слід накласти на рану чисту стерильну серветку й натиснути безпосередньо на рану; підняти кінцівку; якщо кровотеча не зупинена, накласти на рану пов’язку, що тисне, та, якщо можливо, одночасно притиснути артерію
на відстані. Якщо кровотеча не зупинена, накласти джгут.
6. Якщо кровотеча венозна, слід накласти на рану чисту стерильну серветку й здійснити тиск безпосередньо на рану; підняти кінцівку. Якщо кровотеча не зупинена, накласти на рану пов’язку.
7. Покласти постраждалого / постраждалу на спину з ногами, піднятими трохи вище рівня серця, вкрити ковдрою.
допомогою! Венозні кровотечі супроводжуються безперервним витіканням з рани крові темно-червоного кольору. Вони також можуть призвести до значної крововтрати. Щоб їх зупинити, накладають тугу пов’язку, що тисне, а кінцівку підіймають догори. Якщо ушкоджені великі вени, накладають джгут (турнікет). Капілярні кровотечі
непритомність.
2.
3.
4.

rnk.com.ua/ 109439

Будова серця
Серце розташоване всередині грудної порожнини, за грудиною, і зміщене ліворуч від центру. Майже зусібіч воно захищене кістками грудної клітки й має розміри приблизно з кулак. Маса серця в жінок 250–300 г, у чоловіків 300–350 г. У добре підготовлених спортсменів серце


шлуночки (лівий і правий). Ліва й права половини серця розмежовані серцевою перегородкою. Між пе-
: двостулковий (мітральний) у лівій Мал. 12.3. Серцевий



Перекачування крові серцем
дяки скороченням і розслабленням міокарда. Спочатку скорочуються обидва передсердя, проштовхуючи кров до шлуночків. Потім скорочуються шлуночки, виштовхуючи кров до артерій. Після скорочення серце розслаблюється. Таке чергування скорочень, тобто систола (передсердь 0,1 с, шлуночків 0,3 с) і розслаблень (діастола 0,4 с) має назву серцевий цикл (мал. 12.3).
Діастола є довшою, щоб серце могло відпочити між скороченнями.
Частота серцевих
Частота серцевих скорочень (кількість ударів серця за хвилину, ЧСС) дорослої людини в спокійному стані становить 60–80 уд/хв. Під час фізичного навантаження або емоційного хвилювання частота підвищується, під час сну знижується. ЧСС можна встановити, вимірявши пульс (мал. 12.4)
Артеріальний тиск
Коли серце скорочується, воно із силою ви-
штовхує кров в артерії. Тиск крові, який виникає за таких умов, називається артеріальним. Артеріальний тиск найбільший під
час систоли шлуночків (верхній тиск) і най-
менший під час діастоли (нижній тиск). Вимірюється артеріальний тиск у міліметрах ртутного стовпчика (мм рт. ст.) за допомогою тонометра (мал. 12.5, с. 62).
Значення артеріального



Тиск вимірюють на неробочій
(для правшів — це ліва,
шульг — права рука)
Вимірювання проводиться в положенні сидячи
Тіло розслаблене, рука

2.
3.
Відкритий мікрофон
ріодичні електричні імпульси. Далі ці імпульси поширюються провідними шляхами серця, утвореними спеціальними м’язовими клітинами (мал. 12.6). Отримуючи електричний сигнал, м’язові клітини серця збуджуютьться й скорочуються. Таким чином, міокард серця сам утворює електричні імпульси, що активують його ритмічну роботу. Ця властивість називається автоматія. Завдяки їй серце скорочується самостійно. Нервова система може лише прискорювати чи сповільнювати роботу серця. Така властивість притаманна лише серцевому

Провідні шляхи
серйозне порушення?
3. Коли збудження поширюється
допомогою електрокардіографа. Розгляньте електрокар-
наведені нижче. Чим характеризуються


послідовного скорочення передсердь і шлуночків (систоли) та
розслаблення (діастоли). Серцевому м’язу властива автоматія — здатність скорочуватися під впливом власних імпульсів. Мал.




rnk.com.ua/ 109440
§ 13
артерій, коли їхній просвіт звужується внаслідок відкладання в стінках ліпідів, зокрема холестеролу. Звуження просвіту артерій призводить до зменшення надходження крові до тканин і органів, а отже, недоотримання



розвивається стенокардія, що супроводжується відчуттями стиснення, поколювання, печіння або просто болю за грудиною.
Якщо кровообіг крізь судини серця блокується повністю, виникає інфаркт міокарда загибель клітин окремих ділянок серцевого м’яза. Порушення кровообігу в судинах головного
мозку призводить до інсульту загибелі клітин в окремих
інсульт є вкрай
Кардіологія — галузь медицини, яка займається захворюваннями серцево-судинної системи.
Уражені атеросклерозом артерії мають звужений просвіт і втрачають еластичність стінок. Тож збільшується опір, що ускладнює потік крові. Організм намагається відрегулювати
надходження крові до тканин і органів, збільшуючи артеріальний тиск, щоб проштовхнути її крізь звужені судини. Унаслідок цього розвивається гіпертензія, або гіпертонічна хвороба. Підвищений тиск збільшує навантаження на серце, спричиняє гіпертрофію (розростання) міокарда, підвищує ризик інсульту й інфаркту, ушкоджує судини нирок і очей.
Якщо лікар діагностував гіпертонічну хворобу, то необхідно все життя регулярно приймати
призначені лікарем препарати, які
артеріальний тиск. Причини
губи синіють
Перша допомога
Негайно викликати швидку медичну допомогу
Людину зручно посадити, забезпечити
висунути язик)
Порушення мовлення (попросіть сказати щось)
з одного боку (попросіть
руки перед собою)
Порушення зору
Порушення координації
Знепритомнення
Перша допомога
Інформаційно-пошуковий проєкт «Серцева хірургія»
Працюйте в групах. Підготуйте
й презентуйте інформацію
щодо створення й використання:
а) штучного серця; б) клапанів;
в) стентів; г) шунтування судин.
лікарем діагнозу своєчасно лікуватися препаратами, що знижують рівень холестеролу та стримують розвиток атеросклерозу.
до вашої «лікарської спеціалізації».
Порадьте, у яких медичних
закладах України можна пролікуватися, попередньо вивчивши належну інформацію.
(мал. 13.2). Відбувається це через вроджені або набуті дефекти еластичності стінок вен і венозних клапанів. Розвитку захворювання сприяють сидяча робота, малорухливий спосіб життя, необхідність піднімати та носити важке.
Захворювання лімфатичної системи
Найбільш поширеними хворобами лімфатичної системи є запалення лімфатичних вузлів і су-
дин, що порушують відтік лімфи.
Запалення лімфатичних вузлів лімфаденіт провокується інфекціями або травмами.
Запалення лімфовузла супроводжується його збільшенням, почервонінням шкіри навколо, підвищенням температури. Лімфаденіт часто виникає під час грипу, хронічного тонзиліту, ангіни, скарлатини, паротиту та інших інфекційних хвороб.
Коли порушений лімфообіг, може розвинутися лімфостаз, або лімфодема, набряк тканин унаслідок застою лімфи, спричинений вродженими вадами або набутим ушкодженням лімфатичних судин. Ідеться про серцеву
недостатність, хвороби нирок, варикозну хворобу, запалення або вади лімфатичних судин. Набряки кінцівок
Завдання
Визначте, яку інформацію містять
наведені мапи*. Як різняться
країни Європи за смертністю
відбувається в Україні порівняно з іншими країнами?
більш
чи жінки?
ви вважаєте, чому так?
* Pirillo, A., Casula, M., Olmastroni, E. et al. Global epidemiology of dyslipidaemias. Nat Rev Cardiol 18, 689–700 (2021).

частина.
1. Біг на місці: 1 хв.
2. Стрибки: 1 хв.
3. Присідання: 1 хв.
4. Біг на місці: 1 хв.
5. Стрибки через скакалку: 1 хв. Завершення тренування. 5 хв спокійної ходьби. Усього 15 хв.







Мал. 13.3. Стадії (1–4) виникнення лімфостазу, або лімфодеми
1.
інтенсивної терапії, відділеннями реабілітації
і санаторно-курортну реабілітацію. 1986 року Л. Мала
стала фундатором єдиного
в Україні НДІ терапії, названого на її честь.
Опорні точки
Більшість захворювань серцево-судинної системи є наслідками атеросклерозу. Ідеться
3.
4.
5.
6.

rnk.com.ua/ 109441

Транспортування речовин
У невеликих організмів, як-от плоскі та круглі черви, поживні речовини перерозподіляються між клітинами через міжклітинну (тканинну) рідину. Маленькі розміри цих тварин не потребують додаткової системи транспортування речовин до різних відділів тіла.
У великих тварин розвиваються кровоносна та лімфатична системи. Кровоносна система буває замкнена й незамкнена. У замкненій
носній системі судини утворюють замкнене коло; кров циркулює лише судинами. Замкнену кровоносну систему мають кільчасті черви та хребетні тварини. У незамкненій кровоносній системі судини відкриваються в порожнини тіла; кров (у цих тварин її називають гемолімфа) циркулює як судинами, так і порожнинами тіла. Незамкнену кровоносну систему мають молюски та членистоногі.
Кровоносні системи безхребетних Добре розвинену замкнену кровоносну систему мають кільчасті черви (мал. 14.1, с. 70). Вона складається з двох великих судин: спинної


бік. По черевній судині кров потрапляє до органів тіла й повертається в спинну судину.
судини розгалужуються на
черв’яка м’язовий шар?
J
Довідка. Гемолімфа комах безбарвна й не транспортує кисень. У раків, павуків і молюсків кисень
переноситься транспортним білком гемоціаніном, до складу якого входять катіони Купруму, що надає гемолімфі цих тварин блакитного кольору.
Мал. 14.3. Кровоносна система
із зябер або легень потрапляє в передсердя, потім у шлуночок і виштовхується в артерії, що постачають її до органів. Еволюція кровоносної системи хордових тварин
примітивних хордових, як-от

Як
1. У
2. Через
коло кровообігу (вперше з’являється в предків амфібій).
3. Для більш ефективного насичення тканин киснем виникає потреба розділити артеріальний і венозний кровообіги; це стає можливим через ускладнення








3.


rnk.com.ua/ 109442
Дихання властиве багатьом
бактерій до складно побудованих рослин
рин. Дихання це процес, завдяки якому живі організми отримують енергію шляхом окиснення органічних чи неорганічних хімічних сполук. Найпоширенішим окисником є
кисень.
Пригадайте: коли відбуваються хімічні реакції окиснення під час взаємодії метану (органічна речовина) чи сірководню (неорганічна речовина) з киснем, вони супроводжуються виділенням тепла й світла. СН4 + О2 = СО2 + Н2О + тепло
черви та ін.
Як ці організми існують без кисню? Чому відкриття Л. Пастера спричинило «революцію» в науці кінця XIX століття?
Створіть схему дихання в клітинах еукаріот. Зобразіть
клітину, ядро, мітохондрії. Покажіть стрілками

Дослідження «Порівняння вмісту вуглекислого газу у вдихуваному та видихуваному повітрі» rnk.com.ua/108461
надходять за рахунок дифузії. Дрібним організмам
тіла. Це притаманне деяким ракоподібним (дафнії),
(планарії, дощовий черв’як). У разі збільшення розмірів тіла, складності та швидкості обміну речовин у тварин з’являються спеціальні органи дихання. Вони забезпечують
вирости (мал. 15.1). Справжні
в раків (мал. 15.2) і молюсків. Окрім наявності самих зябер, тварини мають забезпечити їхнє ефективне омивання водою, наприклад, за рахунок плавання чи рухів ніжками.
У комах і павуків сформувалися трахеї розгалужені дихальні трубочки, що пронизують усе тіло й починаються на поверхні тіла дихальцями (мал. 15.3). Повітря втягується до трахей під час розширення тіла й виштовхується під час його стиснення.


Мал. 15.3. Дихальця на сегментах гусені продовжуються вглиб тіла тонкими хітиновими трубочками
У деяких безхребетних сформувалися «легені» мішкоподібні утворення для газообміну (наземні молюски, павуки). Вони мають густу сітку капілярів, а повітря до них активно нагнітається роботою м’язів тіла. Так, у равлика ахатини легеня це мішкоподібна складка мантії, що відкривається назовні отвором (мал. 15.4).
Еволюція дихальної системи в хордових тварин







Мал. 15.7.
1.
An animal has a trachea, bronchi, and well-developed lungs with small air sacs. Air is drawn into the lungs by means of intercostal muscle contraction and chest movements. The animal is unable to breathe through its skin due to the presence of horny integuments.


Мал. 15.8.



Дихальна система людини складається з дихальних шляхів: носової порожнини, носоглотки, гортані, трахеї, бронхів і легень органів газообміну між повітрям і кров’ю (мал. 16.1).


Гортань утворена рухомо з’єднаними хрящами та сполучною тканиною. Вона відокремлює дихальні шляхи від глотки й стравоходу (мал. 16.2а) й забезпечує безперешкодне проходження повітря до трахеї. Під час ковтання надгортанний хрящ, як кришка, закриває вхід до гортані, аби їжа не потрапила в дихальні шляхи.
Ще однією функцією гортані є утворення звуків. Тут розташовані голосові зв’язки дві еластичні мембрани з волокон сполучної тканини (мал. 16.2б). Під час утворення звуків вони змикаються за рахунок спеціальних м’язів. Повітря, що виходить крізь голосову щілину, спричиняє їхню вібрацію й утворення звуків певної частоти. Надалі індивідуальне формування тембру голосу й відмінності у звуках відбуваються за участі ротової й носової порожнин, язика, губ, зубів, щелеп, гортані та глотки.




Індивідуальна робота Подивися ролик за QR-кодом і дай відповідь на запитання про те, яка функція слизу та

Анімація «Функція слизу» rnk.com.ua/108462
Легені Парні органи дихання,
Бронхи
Трубочки, армовані хрящами
й гладенькими м’язами.
тонесенькими бронхіолами




(мал. 16.3б, с. 79). Її внутрішня поверхня вистилається миготливим епітелієм.
хи, якими повітря надходить до легень і виходить із них (мал. 16.4). Вентиляція легень.
Надходження та виведення повітря з
забезпечують дихальні рухи грудної клітки, у здійсненні яких беруть участь діафрагма
завдяки тиску внутрішніх органів. Це спричиняє зростання тиску в грудній порожнині й виведення повітря з легень в атмосферу.
Регуляція дихальних рухів. Дихальні рефлекси
Під час фізичних навантажень у крові зростає рівень розчиненого вуглекислого
що сприймають спеціальні рецептори.
на це дихальний центр
разі подразнення рецепторів
лонки дихальних шляхів виникають
чхання
рефлексів також розташовані
мозку. Обидва
і швидким видихом. Вони спрямовані на видалення сторонніх





Резервний об’єм вдиху (близько 1500 мл) Дихальний об’єм (близько 500 мл)
об’єм
(близько 1500 мл) Залишковий об’єм (близько 1000–1500 мл)

(HCO3) він транспортується переважно в розчиненому
дження «Визначення та порівняння дихального об’єму
легень (спірометрія)»
1. Знайдіть в інтернеті за пошуковим запитом «спірометрія» або «методика
й подивіться його.
2. Визначте власні дихальний об’єм і життєву ємність
спірометра, дотримуючись
3. Обчисліть за формулою
них особливостей.
= 40х + 30у – 4400,
4.
2.
3.
4.




rnk.com.ua/ 109444
§ 17
температура, сухий кашель і почервоніння слизової оболонки глотки.
В аптеці вона купила
чи раціональний такий вчинок. Під час яких захворювань лікарі можуть призначати антибіотики?
легень: SARS-CoV-2 (а),
стафілокок (б),
приміщеннях. Мал. 17.1. Поширені збудники
(в) Поміркуйте

дихання. Найбільш поширеними є саме інфекційні захворювання органів дихальної системи. Їх спричинюють віруси та бактерії, які передаються переважно повітряно-крапельним шляхом. Ці збудники разом із краплинками слизу потрапляють у повітря, коли ми видихаємо, та під час чхання чи кашлю. Цей аерозоль, що містить бактерії та віруси, вдихають усі довкола (мал. 17.2). Саме тому хвора людина не має перебувати в місцях скупчення людей, особливо в


руйнує клітинні стінки багатьох бактерій, тоді як білки-антитіла зв’язуються з вірусними частинками й блокують їх.
Спеціальні клітини в складі епітелію виробляють слиз, що, наче клей, затримує віруси й бактерії. За допомогою злагодженого руху війок миготливого епітелію він виводиться
з дихальних шляхів назовні.
Чому ж бар’єрні та захисні функції слизової
оболонки дають збій? Часто причиною є пересихання слизової оболонки, її хімічне (чадний газ, дим, оксиди Сульфуру та Нітрогену) чи фізичне (часточки пилу, піщинки, пил буді-
вельних сумішей) ушкодження. Унаслідок вдихання сухого або холодного повітря відбувається звуження кровоносних судин. Це також знижує захисні властивості слизової.
Шкідливі звички, зокрема паління, є головним фактором розвитку різних захворювань органів дихання. Ще одна причина наявність на слизових оболонках, мигдаликах (мал. 17.3) чи аденоїдах хронічних інфекційних процесів, які періодично активізуються. У такому разі
мигдалики та аденоїди стають джерелом інфекцій і розвитку карієсу, парадонтозу, отитів та захворювань органів дихання.
Інфекційні захворювання органів
дихання
Інфекційні запальні процеси дихальних шляхів і легень можуть спричинятися різними вірусами (аденовіруси, риновіруси та ін.) чи бактеріями (золотистий стафілокок,






дихання. Розвиток астми зумовлений спадковими особливостями імунітету людини. Проте причиною запуску алергічної реакції є фактори середовища: алергени (пил і пилові кліщі, цвілеві гриби та їхні спори), хатні тварини (шерсть, пір’я, слина), таргани, засоби побутової

1-ша стадія



Про загальні заходи профілактики захворювань органів дихання ви дізналися з уроків «Здоров’я, безпека та добробут» і вивчення біології в 7-му класі. До них належать:
проведення профілактичних щеплень;
дотримання правил комунальної гігієни (регулярне провітрювання приміщення, вологе прибирання, боротьба з пилом і вентиляція);
карантин, обмеження відвідування місць масового скупчення людей, ізоляція хворого;
дотримання правил особистої гігієни (використання маски в закритих приміщеннях, миття рук та ін.);
підвищення опірності організму завдяки раціональному харчуванню та дотриманню

бронхів. Порушення голосу часто трапляються в тих людей,

Тоді голос стає
хриплим, виникає кашель, порушення дихання. Лікування хвороби передбачає голосовий спокій (мал. 17.9). X
не перенапружувати голос;
вчасно лікувати респіраторні захворювання;
відмовитися від паління й алкоголю;


Способи
Для підтримання
а також використовують різні джерела енергії. Цей процес називається живленням (схема 10, с. 90).
Живлення — це отримання з навколишнього середовища речовин та енергії для життєдіяльності.
того, як їжа













Розгляньте схему 10. Знайдіть на схемі й назвіть по одній тварині, яка є: фітофагом, зоофагом, хижаком, фільтрувальником, сапрофагом, паразитом, консументом першого порядку, консументом другого порядку, редуцентом. Як живиться названа вами тварина? Які має пристосування до живлення?
Вони поглинають макромолекули
великі харчові частинки (клітини та клітинні фрагменти бактерій, мікроводоростей) шляхом фагоцитозу (мал. 18.1). Усередині клітин харчові
частинки розщеплюються в травних вакуолях, що містять травні ферменти. Неперетравлені рештки виводяться шляхом екзоцитозу.
Фагоцитоз — це захоплення і поглинання клітиною великих частинок за участю клітинної мембрани.
У багатоклітинних губок травлення також внутрішньоклітинне. Але вони вже мають спеціалізовані для травлення клітини хоаноцити, які вистилають внутрішню порожнину тіла. Хоаноцити поглинають поживні частинки й перетравлюють їх у спеціалізованих органелах лізосомах. Далі перетравлені речовини
передаються іншим клітинам (мал. 18.2).
Порожнинне травлення
Більшість видів тварин перетравлюють їжу позаклітинно, усередині травної порожнини. У цьому разі травні ферменти вивільняються в травну порожнину, а клітини всмоктують
уже перетравлені речовини. Це порожнинне травлення. У жалких, наприклад у гідр або
медуз, у центрі тіла є кишкова порожнина, яка має лише один отвір (мал. 18.3, с. 92).
Шар спеціалізованих клітин, що вистилає порожнину, виділяє до неї травні ферменти. Після травлення в порожнині
травлення внутрішньоклітинно. Багато плоских червів







печінка, підшлункова залоза, слинні залози (мал. 18.5в).
У кишці формуються відділи з різними функціями. Наприклад, перший відділ кишки спеціалізується на перетравленні їжі, наступні на всмоктуванні поживних речовин.
Запитання і завдання
1. Чим відрізняються типи живлення черевоногих і
2.
А craw is an enlarged part of the esophagus in some animals, where food is accumulated, stored, and sometimes pre-digested.
А craw is an enlarged part of the esophagus in some animals, where food is accumulated, stored, and sometimes pre-digested. For example, in bees, the initial stages of processing nectar into honey occur in the craw. The earthworm’s craw allows for the rapid intake of large amounts of food, that can be stored and used over a long period. The food then enters the stomach, which has thick muscular walls. There, it is broken down by mixing and grinding, a process aided by small stones ingested with food.



Травна система людини
Травна система є системою органів, за допомогою якої ми поглинаємо, перетравлюємо їжу й засвоюємо поживні речовини. Шлунково-кишковий тракт складається з ротової порожнини, глотки, стравоходу, шлунка, тонкої й товстої кишки. Додаткові органи травлення подрібнюють їжу за допомогою жування та виділяють травні соки. Це зуби, язик, слинні
можуть бути
наслідки?

1.
2.

Травні ферменти
У ротовій порожнині починається травлення вуглеводів. Їжа пережовується, змочується слиною й формується в грудку для ковтання.
За допомогою зубів починається механічне травлення, пережовування їжі. Язик тестує їжу на смак і перемішує її зі слиною, щоб
допомогти її розщепити. Слинні залози виділяють слину, яка містить травні ферменти й починає хімічне розщеплення вуглеводів.
Слина виділяється трьома парами слинних залоз: під’язиковими, піднижньощелепними та привушними (мал. 19.2). Основним травним ферментом слини є амілаза. Вона розщеплює складні вуглеводи (крохмаль) на малі молекули мальтози та глюкози. Завдяки амілазі
в ротовій порожнині починається травлення
таких продуктів: макарони, картопля, рис, хліб та ін. Амілаза слини працює в нейтральному та слабколужному середовищі.
Слина також містить лізоцим речовину з антибактеріальною дією, що знешкоджує багатьох бактерій.
Будова й функції









Людина, як і
ссавці,
диференційовані зуби: різні за формою і функціями (мал. 19.4, с. 95). Різці мають гострий край, яким ми відкушуємо їжу. Ікла допомагають розколювати та відривати шматки їжі. Малі корінні зуби (премоляри) подрібнюють їжу, великі корінні зуби (моляри) виконують основну роботу з її пережовування або розтирання. Перші зуби молочні з’являються

Стравохід
Коли ми ковтаємо їжу, вона проходить крізь глотку до стравоходу. Стравохід це м’язова трубка завдовжки близько 25 см, яка веде до шлунка. Щоб проштовхнути їжу, м’язи стравоходу хвилеподібно скорочуються. Це називається перистальтикою (мал. 19.5). М’язи, які забезпечують перистальтику, гладенькі, їхня робота не залежить від нашої свідомості.
Шлунок, його будова та функції Шлунок є порожнистим м’язовим органом, у якому починається травлення білків (мал. 19.6; таблиця 5). Обсяг
ється зі шлунковим соком.
лому середовищі
й припиняється травлення вуглеводів. Замість
цього починається травлення білків
пепсину. Із часом у шлунку формується





rnk.com.ua/ 109447
«Ти в мене вже в печінці сидиш», — так висловлюються
набридлу людину, яка перешкоджає нормальному процесу життя.
До чого тут жовч і печінка?
Чому виникли такі
неперетравлені й зайві речовини формують калові маси й виходять з організму.
Травлення в тонкій кишці
У тонкій кишці завершується травлення, і всі поживні речовини всмоктуються в кров. Першим відділом тонкої кишки є дванадцятипала кишка, куди відкриваються протоки підшлункової залози
сік, багатий на травні ферменти. Трипсин і хімотрипсин
гемоглобіну. У клітинах
печінки відкладається запасний вуглевод — глікоген
Дванадцятипала кишка
Першій відділ тонкої

міхура окремими жовчними протоками надходить у дванадцятипалу кишку. Жовч емульгує
жири. Це означає, що в процесі емульгації великі жирові краплі подрібнюються на мікроскопічні й наче «розчиняються» у воді, утворюючи з нею емульсію (мал. 20.3). Це дає
змогу ліпазам почати розщеплювати молекули жирів. Без емульгації жовчю кишкові ліпази не можуть розщеплювати жири.
Дрібні залози тонкої кишки також виділяють
кишковий сік, який містить слиз, гідрокарбонати та додаткові травні ферменти.
Моделювання емульгації жирів
поверхнево-активними речовинами Вам знадобляться: скляна
поверхнево-активна


Лімфатичний капіляр
Mікроворсинки

Кровоносні капіляри
Мал. 20.4. Мікрофотографія
речовин
речовини всмоктуються клітинами епітелію тонкої кишки. Далі амінокислоти та цукри надходять у кровоносні капіляри, а жири та інші ліпіди у лімфатичні капіляри ворсинок слизової кишки. Звідси вони транспортуються до печінки. Внутрішня (слизова) оболонка тонкої кишки має численні складки ворсинки, завдовжки десь по 1 мм (мал. 20.4). Кожна ворсинка вкрита тисячами мікроворсинок довжиною приблизно 1 мкм. Ворсинки й мікроворсинки збільшують
(іони Натрію, Калію, Хлору та ін.). Рух хімусу відбувається
якщо їжа містить багато рослинних волокон (клітковини). Поступово хімус перетворюється
кишці людини міститься приблизно 1013–1014 бактерій-симбіонтів, що належать до 300–1000 різних


rnk.com.ua/ 109448
у транспортуванні речовин у клітини й назовні, а катіони Кальцію у процесах зсідання крові та скорочення м’язів. Нерозчинні солі Кальцію забезпечують міцність кісток і зубів, а катіон Феруму, що входить до складу гемоглобіну, бере участь у транспортуванні кисню.
До складу молекул органічних речовин входять атоми Карбону, Гідрогену, Оксигену, Нітрогену. Їх називають органогенними елементами, і вони всі разом складають 96–98 % маси тіла в будь-яких живих організмів.
Вітаміни
Вітаміни це органічні речовини, необхідні організму для нормального
у невеликих кількостях. Вітаміни є «помічниками» ферментів, без яких ферменти


Авітаміноз — порушення, що виникає через
відсутність окремих вітамінів.
Гіповітаміноз — порушення, яке виникає через нестачу окремих вітамінів.
Гіпервітаміноз — порушення, яке виникає через надлишок окремих вітамінів.
Основними поживними речовинами в

риба, яйця, молоко, сир, бобові, горіхи
Є ферментами, гормонами, транспортними білками, забезпечують імунітет, беруть участь у відтворенні клітин.
енергії. Швидким джерелом енергії є вуглеводи, особливо глюкоза. Глюкоза, що
потрапила з їжею, майже одразу засвоюється організмом. А от для травлення крохмалю необхідний триваліший час. Білки використовуються як джерело енергії тоді, коли інших
джерел бракує. Харчова цінність продуктів визначається тим, які компоненти і
містять, яку енергетичну цінність мають.
сока харчова цінність є
ність
кислот, які не синтезуються
можуть бути замінені іншими речовинами.
Раціональне харчування
Раціональне харчування це
збалансованим складом компонентів і з
мальною енергетичною цінністю. Збалансованим раціоном уважається таке співвідношення
компонентів їжі: вуглеводи 55–60 % денної
калорійності, жири 30 %, білки 10–15 %. У харчовому раціоні дорослих мають
переважати овочі, зернові продукти та продукти, що містять повноцінний білок тваринного походження.
Підтримка нормальної
складником раціонального






1.





rnk.com.ua/ 109449
руйнуються під дією органічних кислот, які виділяються численними бактеріями ротової порожнини. Ці бактерії живляться залишками нашої їжі. Карієс виникає через недостатню
гігієну порожнини рота, переважання в раціоні м’якої їжі й вуглеводів. Розвиток карієсу
спричиняє нестача мінералів і вітамінів, які беруть участь у формуванні твердих тканин зубів: Кальцію, Флуору, Фосфору, вітаміну С та інших. До ушкодження емалі зубів також
призводить вживання гарячих, холодних чи
кислих напоїв. Руйнування зуба відбувається
внаслідок бактеріальної інфекції його тканин. X Правила профілактики









Анімація «Імплантація зуба» rnk.com.ua/108474

Зараження відбувається через
ти: брудні руки, речі, поверхні. Ротавірусна інфекція небезпечна сильним зневодненням організму. Щоб компенсувати втрату води та мінеральних речовин, хворим
спеціальні регідратаційні розчини. Проти ротавірусу розроблено вакцину








. Симптомами є втрата апетиту, біль у животі, нудота. У великій кількості ці паразити можуть закупорити просвіт кишки або жовчних протоків, порушуючи проходження їжі та відтік жовчі. Запалення органів травної системи
Найпоширеніше захворювання органів травної
гастриту є
шлунка поява ділянок, на яких слизова оболонка руйнується (мал. 22.4). Симптоми цих захворювань
хелікобактер (Helicobacter pylori). Виникненню гастриту сприяють умови неправильного харчування. Постійне
няє подразнення слизової оболонки шлунка. Хронічний стрес, паління і вживання алкоголю теж сприяють розвитку захворювання. Гострим запаленням травної системи є апендицит бактеріальне запалення червоподібного відростка сліпої кишки. Больовий напад за умов гострого апендициту, як правило, розвивається раптово. У разі апедициту людині треба забезпечити

rnk.com.ua/

Виділення як властивість живого
Виділення є процесом виведення з організму різноманітних речовин: шкідливих і непотріб-
них продуктів метаболізму, вуглекислого газу, солей, надлишку води. У вигляді амоніаку, сечовини й сечової кислоти виділяються нітрогенумісні продукти розпаду білків і нуклеїно-
вих кислот. Цей процес забезпечує підтримку сталості параметрів внутрішнього середовища організму гомеостазу. Поміркуйте
який зовсім нічого не виділяє в навколишнє середовище?

Поміркуйте
Відомо, що такі дерева, як сосна, ялиця, кедр, ялина, модрина, виділяють смолисту речовину в суміші з ефірними оліями. Коли й навіщо це
відбувається? Чи має це адаптивне значення?
Яке відношення має ця смола до бурштину?





Виділення — це процес звільнення організму від кінцевих
сполук. Еволюція
системи
Одноклітинні організми (до прикладу, амеби або інфузорії-туфельки) виводять продукти життєдіяльності через поверхню клітини. У прісноводних одноклітинних є скоротливі вакуолі, які видаляють надлишок води.



нирка). Протонефридії складаються із зірчастої клітини, що має війки, та видільної трубочки (мал. 23.1). Рух війок забезпечує виведення розчинених речовин у трубочки, що відкриваються назовні
тіла. Круглі черви також мають спеціалізовані видільні трубочки.
У кільчастих червів органи виділення побудовані складніше. Це трубчасті звивисті канальці, які відкриваються одним кінцем у вторинну порожнину тіла, а другим назовні (мал. 23.2). Канальцями рухається рідина
первинна сеча. У них відбувається реабсорбція, тобто зворотне всмоктування необхідних органічних речовин, солей і води. Продукти ж обміну далі виводяться назовні. Така система
канальців дістала назву мета-нефридії (від грец. «мета»



(мал. 23.4, с. 111). Вони розташовані в головному відділі й виглядають, як пухирці з вивідними канальцями, які відкриваються назовні в основі довгих вусиків. У комах і павукоподібних органи виділення складаються з трубочок кількістю
двох до кількох сотень. Вони дістали назву мальпігієві судини (мал. 23.5). У комах їх значно
через сечовидільний канал. Видільна система хордових ускладнюється через опанування цими тваринами суходолу.
Видільна система риб складається з парних стрічкоподібних нирок, які лежать уздовж хребта, сечоводів і сечового міхура. Саме в сечовому міхурі сеча накопичується й виводиться назовні (мал. 23.6). Крізь зябра та із сечею в риб здебільшого виділяється амоніак (NH3) як кінцевий
земноводних і плазунів сеча утворюється нирками, розташованими

Мал. 23.6. Внутрішня

Мал. 23.7. Видільна система черепахи
1.
2.
у якому немає води. Дізнайтеся, завдяки яким пристосуванням це відбувається. Навіщо верблюдам потрібне таке пристосування?
3. Єдиний вид птахів,

умов існування.



rnk.com.ua/ 109451
запитання «Де розташована вбиральня?»
ставлять найчастіше?
Які правила диктує нам наша
видільна система? Що ми маємо обов’язково
знати про особливості
її будови та функціонування?

середовища (гомеостазу), виконують секреторну функцію. Нирки розміщені в заочеревинному просторі, обабіч поперекового відділу хребта. Кожна нирка має бобоподібну форму, завдовжки
12 см, ширина 6 см і
близько 120–150 грамів. Увігнутий внутрішній край нирки обернений до хребта. Усередині нього є заглиблення, що називається воротами нирки. Крізь них проходять ниркові кровоносні судини (ниркові артерії та ниркові вени). Від нирок відходять сечоводи, якими вторинна сеча потрапляє
назовні (мал. 24.1). Нирка складається з кіркової та

зливаються вершинами, утворюючи сосочки. На верхівці кожного сосочка відкриваються
ниркові канальці, які виводять сечу в чашечки.
Малі ниркові чашечки зливаються між собою
й формують 2–3 великі чашечки. Натомість
великі ниркові чашечки зливаються в ниркову
миску. Ниркова миска звужується й переходить у сечовід (мал. 24.2).
Функції сечовидільної системи людини.
Сечоутворення
Нирки людини виконують різноманітні функції (схема 12). Вони підтримують водний J

Мал. 24.3.
нефрон складається з клубочка, огорнутого капсулою, і звивистих канальців. Клубочки розташовані в кірковому шарі нирки, а канальці у мозковому. Канальці зливаються в сечозбірні трубки, які відкриваються в малі чашки нирки. Однією з основних функцій нирок є сечоутворення й виведення сечі, що містить розчинені у воді продукти обміну.
Сеча (лат. urina) — біологічна рідина, відфільтрована плазма крові, у складі якої з організму
речовин. Як відокремити корисні

цього процесу і корисні, і шкідливі речовини потрапляють у фільтрат первинну сечу, що стікає в капсулу. У нормі формені елементи та білки крові не проходять фільтраційний бар’єр. Фільтрація відбувається постійно, тож загалом за добу утворюється 150–180 л первинної сечі.
й інші продукти обміну. Такий процес називають секрецією. Після проходження всієї довжини канальця нефрона в сечозбірній трубці утворюється вторинна
сеча. Це невелика кількість води, що містить солі, сечовину, сечову кислоту, амоніак та інші
продукти обміну. У
не має бути глюкози, білків чи
добу утворюється 1,2–1,8 л
(таблиця 7).
Таблиця


J
Довідка. У сфінктері, крім гладких м’язів, які забезпечують мимовільне сечовипускання, є також посмуговані м’язи, які керуються довільно.
У немовляти працює лише сфінктер мимовільного сечовипускання. Із часом дитина навчається керувати іншим м’язом — сфінктером, який підкоряється волі людини. Завдяки цьому дитина починає

rnk.com.ua/ 109452

Порушення роботи
сечовиділення
Захворювання
організму
речовин, що мали б вивестися із сечею.
За рахунок видільної функції нирки регулюють водно-сольовий обмін, тобто здійснюють осморегуляцію. Якщо є надлишок води в організмі, то нирки виділяють розбавлену сечу, а за нестачі води більш концентровану, здійснюючи таким чином регуляцію вмісту води в організмі. Затримуючи певні йони (Na+, K+) або посилюючи їхнє виведення з організму, нирки відіграють важливу роль у підтриман-
ні гомеостазу, тобто нормальної концентрації
йонів солей (0,9 NaCl). Під час погіршення роботи нирок виникають порушення гомеостазу, які
Уретрит
Цистит
Сечокам’яна хвороба
Запалення сечівника, що спричиняється
такими бактеріями, як стрептококи,
кишкова паличка, або іншими
мікроорганізмами
Запалення слизової оболонки сечового
міхура внаслідок проникнення в нього кишкової палички, стафілококів, стрептококів
Відкладення солей у нирках і сечовивідних шляхах

що перекрив
сечі
тіла, набряк обличчя й кінцівок, головний біль, нудота, наявність крові в сечі
Часте й болісне сечовипускання або позиви до сечовипускання
Часті позиви до сечовипускання, біль, свербіж, печіння під час сечовипускання
Сильний біль у ділянці нирок, утруднене відтікання сечі
Будьте активними, оскільки фізичні навантаження
допомагають нормалізувати артеріальний тиск
і покращити циркуляцію
крові в нирках
Пам’ятайте, що алкоголь є шкідливим для сечовидільної системи. Етиловий спирт цих напоїв — це отрута для нефронів, епітелію ниркових чашок і мисок
Враховуйте, що етиловий спирт спричиняє запалення нирок, або
захворювання органів статевої системи, зловживання алкогольними напоями, жирними чи гострими стравами тощо.
Задля якісного здорового життя слід здійснювати профілактику захворювань нирок, як-от: збалансовано харчуватися, своєчасно лікувати захворювання зубів і органів травлення й дихання, щоденно дотримуватися особистої гігієни тощо. На основі цього лікарі
прості
одне з
профілактики захворювань видільної системи за методом «PRES» (від англ. Position-ReasonExplanation or Example — Summary). Використовуйте такі фрази: «Я вважаю…», «Тому що…», «Наприклад…», «Отже, можна зробити такий висновок…».
2.
3.


rnk.com.ua/ 109453

внутрішніх органів і проникненню хвороботворних бактерій і вірусів, шкіра

є основним складником шкіри. У ній розміщені рецептори,
з поверхні шкіри випаровується приблизно 500 мл поту, з яким виділяються солі, сечо-
вина й інші метаболіти. У підшкірній жировій клітковині відкладається жир як резервна речовина. Ба більше, під впливом ультрафіолету в шкірі синтезується вітамін D, тобто шкіра
здійснює функцію обміну. У шкірі розташовані тактильні, температурні та больові рецептори, які забезпечують виконання нею рецепторної функції (схема 14).
Функції шкіри
Шкіра складається з трьох
епідермісу, дерми (власне шкіри) та підшкірної клітковини (мал. 26.1). З-поміж шкірних

Низька пористість волосся
Середня пористість волосся
Висока пористість волосся


Мал. 26.2. Колір волосся
залежить від наявності та кількості пігменту — меланіну. З віком синтез цього пігменту зменшується, а у волоссі збільшується
кількість повітряних пухирців — це призводить до посивіння

STEAM-проєкт «Вплив на стан шкіри
1.
2.
3. Якщо волосинка швидко опускається на дно склянки, ваше волосся має високу пористість. Якщо волосся залишиться на поверхні води, то ваше волосся має низьку пористість.
цибулину,
складається з епітеліальних клітин, здатних до поділу. Саме за рахунок цього волосся й росте (мал. 26.1, с. 123). Колір волосся залежить від пігменту меланіну (мал. 26.2).
Волосяний покрив людини значно менший, ніж в інших ссавців.


(мал. 26.3).
Захворювання шкіри
Шкіра, як і інші органи, може
ушкоджень. За походженням захворювання шкіри поділяють на:
інфекційні, які спричинені шкідливими мікроорганізмами;
неінфекційні, які можуть бути спричинені
порушенням обміну речовин, пораненнями, дією хімічних речовин, забрудненням середовища, спадковими чинниками тощо.
Досить часто шкіра відображає функціональ-
ний стан усіх органів і систем організму (таблиця 9). Тому слід приділяти особливу увагу своїй шкірі та в
томів звертатися до лікаря
Захворювання шкіри та нігтів, спричинені грибами
Короста
подальшим розвитком у них бактерій
Ураження шкіри або її похідних паразитичними мікроскопічними грибами
Потрапляння в шкіру людини
«Ultraviolet (UV) rays from the sun can harm our skin. Excessive exposure to UV rays can lead to skin problems, such as dryness or even skin cancer. To protect our skin, it’s important to wear sunscreen, hats, and sunglasses, especially when the sun is strong. Staying in the shade or wearing protective clothing also helps to prevent UV damage».
Запалені вузлики, утворені сальними залозами переважно на шкірі обличчя, спини, плечей
Почервоніння, розм’якшення, розшарування шкіри, зміна кольору та структури нігтів, ушкодження волосся

Припинити контакт із джерелом опіку. Зняти гарячий, обгорілий одяг або одяг, що тліє, однак НЕ чіпати речей, що прилипли до шкіри
ментальне здоров’я, стресові ситуації, рівень фізичного навантаження, клімат. Слід завжди стежити за чистотою та здоров’ям своєї шкіри (схема 15)!
Опіки й обмороження. Перша допомога
Опіки це ушкодження шкіри, що виникають через контакт із вогнем, розігрітим предметом чи речовиною або з агресивними хімічними речовинами, до прикладу, кислотами чи лугами. Отриманий опік супроводжується почервонінням, лущенням шкіри, набряками й пухирцями. Глибокі опіки призводять до обвуглення тканин. При термічних опіках на уражене місце накладають стерильну

ураження



вуха та ін. Ознаки обмороження: зміна кольору
воскова шкіра, тверда
Під час обмороження слід перенести потерпілого / потерпілу

rnk.com.ua/ 109454

Подразливість
біль, то дуже хочемо його позбутися. А ось деякі
люди взагалі не відчувають фізичного болю, але вони
мам і є основою пристосувальних реакцій на вплив довкілля. Подразниками можуть бути будь-які чинники: світло, температура, звук, механічна дія, поживні речовини та ін. Організми, у яких немає нервової системи (рослини, найпростіші), реагують на подразники, змінюючи характер руху (таксиси) або ростові процеси (настії та тропізми). Реакції багатоклітинних тварин на подразники здійснюються за допомогою рефлексів і
Подразливість
організмів
Найпростішою формою подразливості є таксиси, які спостерігаються в мікроорганізмів (бактерій, одноклітинних еукаріотів) і деяких клітин багатоклітинних тварин (сперматозоїди, лейкоцити).
Завдяки таксисам найпростіші уникають несприятливих умов, знаходять їжу та ін. Інфузорія-туфелька пересувається в бік їжі, а евглена зелена до освітленої частини водойми, бо їй необхідне світло для фотосинтезу. Реакцію на світло називають фототаксисом, на хімічні речовини хемотаксисом, на температуру термотаксисом.
Таксиси можуть бути позитивними, якщо організм рухається в бік подразника, і негативними, якщо організм рухається від нього. Прикладом позитивного фототаксису є спрямований рух джгутикових організмів, що мають світлочутливе вічко (евглена зелена, хламідомонада), з неосвітлених місць до освітлених (мал. 27.1а). Однак, якщо світло стає занадто інтенсивним, спостерігається негативний фототаксис (мал. 27.1б). Тобто один і той самий
подразник різної інтенсивності може викликати як позитивну, так і негативну відповідь.
Позитивний хемотаксис виявляють найпростіші
організми в пошуках їжі; наприклад, кишкова паличка Escherichia coli має позитивний хемотаксис на градієнт цукру. Завдяки позитивному хемотаксису на речовини, що виділяються яйцеклітиною, сперматозоїди рухаються їй назустріч. Лейкоцити переміщуються








рослин на дію подразника. Геотропізми виникають у відповідь на дію земного тяжіння, фототропізми (або геліотропізми, від «геліос» сонце) у відповідь на світло, хемотропізми
хімічні речовини (мал. 27.2). Тропізми також бувають негативними та позитивними. Корені рослин завжди спрямовані вниз це приклад позитивного геотропізму. Стебло згинається в напрямку до світла це позитивний фототропізм. Завдяки позитивному фототропізму
Багатоклітинним
у тварин
швидкі та різноманітні реакції, що здійснюються за
участю нервової системи, рефлекси. Подразнення сприймаються через рецептори.
Рецептор — спеціалізована структура (клітина
або нервове закінчення нейрона), що сприймає
подразники із зовнішнього або внутрішнього середовища й перетворює їх на нервові імпульси.
Реакції організму на подразнення рецепторів здійснюються через рефлекси.
Подразниками, які активують ті чи інші рецептори, можуть бути світло, механічний тиск, температура, хімічні речовини, зміна електричного й магнітного поля. Найпростіші рецептори складаються з однієї клітини (наприклад, рецептори дотику в шкірі). Розрізняють два типи рефлексів: безумовні та умовні. Безумовні рефлекси завжди вроджені й однакові в усіх представників одного виду. Скажімо, у дитинчат усіх ссавців добре виражений смоктальний рефлекс, завдяки якому вони одразу після народження вживають материнське молоко. Орієнтувальний рефлекс (спрямування уваги в бік несподіваного звуку, яскравого спалаху) допомагає з’ясувати джерело сигналу й оцінити його небезпеку.
Програма дій, що складається з низки послідовностей безумовних





2.
3.
на вплив довкілля.
4.
Key FM, Abdul-Aziz MA, Mundry R, Peter BM, Sekar A, D’Amato M, Dennis MY, Schmidt JM, Andrés AM. Human local adaptation of the TRPM8 cold receptor along a latitudinal cline. PLoS Genet. 2018 May 3;14(5):e1007298.

rnk.com.ua/ 109455

Дифузна нервова система
У тому, як тварини реагують на те, що відбувається навколо, величезну роль відіграє нервова система. Найбільш просту нервову систему мають Жалкі (Кишковопорожнинні). Їхні нервові клітини розміщуються в тілі дифузно (невпорядковано), а численні відростки нервових клітин утворюють нервову мережу (мал. 28.1). Таку нервову систему називають сітчастою, або дифузною. Зовнішнє подразнення поширюється по всіх клітинах нервової мережі, і реакція охоплює всі частини організму. Наприклад, якщо вколоти голкою прісноводну гідру, усе її тіло стиснеться в грудочку.
Стовбурова нервова система
У більшості тварин нервові клітини згруповані в певних ділянках тіла. Так, у плоских і круглих червів скупчення нервових клітин утворюють головні
(ганглії), від яких уздовж тіла тягнуться


Мал. 28.2.


Мал. 28.3.
сигнали складних органів чуття, завдяки чому


Спілкування через обмін хімічними, слуховими, зоровими та тактильними стимулами
Побудова складних споруд


Запасання їжі та турбота про нащадків
Мал. 28.5. Складна інстинктивна поведінка суспільних
(правий і лівий) ганглії розміщені в різних частинах тіла. Ганглії
внутрішні органи (мал. 28.6). Від гангліїв тягнуться нервові ланцюжки.
У головоногих молюсків великі ганглії зливаються й утворюють головний мозок, укритий скупченням тіл нейронів корою. Така висока концентрація нервових клітин забезпечує вдосконалення органів чуття (мал. 28.7). Роз-
винена нервова система каракатиць, кальмарів і восьминогів дає підстави вважати їх найбільш «розумними» з-поміж безхребетних тварин. Вони здатні спілкуватися, навчатися,

Мал. 28.6. Розкидано-вузлова нервова система






1.

2.
3.
4.


Нервова система є сукупністю структур, яка координує діяльність
середовища.
імпульси передаються
настільки швидко й звідки
організм знає, як реагувати?
Нервова тканина та її клітини
Робота нервової системи
та нейроглії




інтернейрон)
сигнали


закінчується в пальцях
Нейрони поділяють на кілька типів (мал. 29.2).
Нейроглія містить різні за
дженням клітини: астроцити, клітини Шванна, олігодендроцити, мікроглію та ін. Вони виконують допоміжні функції: підтримують гомеостаз нервової тканини, забезпечують живлення й захист нейронів, створюють умови для проходження нервового імпульсу (мал. 29.3).



«Нервова система» rnk.com.ua/109385
. Більшість синапсів є хімічними, хоча є й електричні.
Хімічний синапс працює так (мал. 29.4). Коли нервовий імпульс досягає кінця аксона, через пресинаптичну
ну вивільняються молекули нейромедіатора («посередника»). Нейромедіатор зв’язується


Від головного мозку відходить 12 пар черепно-мозкових нервів, від спинного мозку 31 пара спинно-мозкових
забезпечує передачу сигналів
всіма частинами тіла.
Спинний мозок
Спинний мозок є частиною ЦНС, що проводить нервові сигнали між головним мозком та іншими частинами тіла і є центром здійснення багатьох рефлексів. Він розташований
у спинномозковому каналі хребта, має діаметр 1–1,5 см, завдовжки 40–45 см.
Спинний мозок укритий мозковими оболонками, які живлять його й захищають від ушкоджень. Усередині спинного мозку проходить центральний канал зі спинномозковою ріди-
ною, яка забезпечує обмін речовин і захищає
мозок від травм.
Спинний мозок містить білу й сіру речовину (мал. 29.6). Сіра речовина утворена скупченням тіл нейронів, біла речовина укритими мієліном аксонами. Аксони білої речовини утворюють провідні шляхи спинного мозку. Висхідні (чутливі) шляхи
імпульси до





скорочується, і нога розгинається. Сукупність структур і шляхів, задіяних у рефлексі, утворюють рефлекторну дугу. Рефлекси здійснюються за участю принаймні двох нейронів: чутливого й рухового. У дугах більшості рефлексів є також проміжні нейрони.
Рефлекторна функція спинного
гу організму швидко реагувати на
подразники: людина прибирає
2.
3.
4. Розгляньте малюнок.






людини не існує. Наукові дослідження виявили, що інтелектуальні здібності визначаються кількістю контактів між нейронами, їхнім живленням, швидкістю проведення нервового імпульсу. А ще роботою синапсів, станом мієлінових оболонок та іншими факторами. Як і спинний мозок, головний укритий трьома мозковими оболонками: м’якою, павутинною та твердою (мал. 30.1). Оболонки захищають його від ушкоджень та інфекційних агентів, містять кровоносні судини, що живлять нервову тканину. Усередині мозку розміщені шлуночки порожнини, які
Відділи
Головний мозок людини складається з п’яти
відділів: довгастий, задній (міст і мозочок), середній, проміжний і кінцевий мозок (мал. 30.3). Довгастий мозок, міст і середній мозок утворюють стовбур головного мозку.
Мал. 30.3. Відділи головного мозку




rnk.com.ua/ 109458

Функціональна класифікація
системи
Функціонально нервову систему
соматичну й вегетативну (схема 17).
Соматична нервова система (від грец. sоma тіло) контролює роботу
кож збирає й передає інформацію
чуття та рецепторів тіла.
вільні рухи.
Вегетативна нервова система (ВНС) (від лат. vegetativus рослинний) регулює роботу глад-

системи є кора головного мозку, вегетативної гіпоталамус.

рухові команди до органів. Вони утворені
аксонами рухових нейронів. Змішані нерви
передають як сенсорні, так і рухові сигнали.
Спинномозкові нерви (мал. 29.7, с. 142) є змішаними, передають сенсорну інформацію в спинний мозок і рухові команди зі спин-
ного мозку. Вони іннервують шкіру, скелетні
м’язи й органи чуття відповідних сегментів тіла (мал. 31.2).
Черепно-мозкові нерви передають інформацію до головного мозку та з нього. Серед них є чутливі (I, II, VIII пари), рухові (IV, VI, XI, XII) та змішані (III, V, VII, IX, X). Вони іннервують ніс, очі, рот, язик, вуха, шкіру обличчя, шию, плечі та передають інформацію від органів зору, слуху, нюху, смаку й вестибулярного апарата (див. табл. під QRкодом).
Завдяки трійчастому нерву ми відчуваємо обличчя та слизові оболонки носа й рота (мал. 31.3). Лицьовий нерв іннервує мімічні м’язи. Найдовшим із черепно-мозкових нервів є блукаючий нерв, або вагус, який проходить майже по всьому тілу. Він забезпечує як соматичну, так і
голови,





1.
2.
4.
The sympathetic nervous system is often referred to as the «fight or flight» system, while the parasympathetic nervous system is often considered as the «rest and digest» system. In many cases, these systems have opposing effects, where one system activates a physiological response and the other inhibits it.




rnk.com.ua/ 109459

єгиптян? Які із зображених символів не відповідають чуттям? Що таке «шосте» чуття, про яке так часто згадують? нюх зір думки

ху вітру, і різні молекули, що створюють усе розмаїття запахів і смаків. Усі ці подразники, або стимули, це фактори зовнішнього або внутрішнього середовища. Сприймаючи їх, організм отримує інформацію про події в цьому середовищі. Пригадаймо з уроків інформатики, як вводиться інформація в комп’ютер. Для цього є пристрій введення, наприклад, клавіатура. Натискаючи на клавіші (механічна енергія), ми створюємо стимули, які кодуються в електричні сигнали. Вони передаються





клітина або нервові закінчення (дендрити), що сприймають стимул і перетворюють його на електричні імпульси. Усі нервові імпульси однакові. Тому для кодування інформації важлива частота цих імпульсів. Спрощено можна уявити, що в нервовій системі інформація кодується за
принципом, схожим на двійковий код: наявність імпульсу 1, а відсутність імпульсу 0 (мал. 32.2).
Існують різні типи рецепторів, які
сприймати світло (фоторецептори); молекули пахучих речовин (хеморецептори);
та позицію голови





Знайдіть
Виконайте пошукову роботу, знайдіть
внутрішні подразники, отримуючи інформацію про стан організму.

(Karl von Frisch). Мал.

Різноманіття сенсорних систем у тварин
У тварин для сприймання різних подразників є сенсорні системи: зорова, слухова, нюхова, смакова, рівноваги, дотику, температури, руху (рецептори м’язів і сухожиль). Вони наявні в переважної більшості тварин і людини. Проте, залежно від пристосувань тварин до середовища існування, ці сенсорні системи можуть бути різної складності (мал. 32.3, с. 153).
рах, зорова сенсорна система спрощується, тоді провідними чуттями
(мал. 32.3г, с. 153). Натомість у денних тварин тропічних лісів добре розвинений колірний зір (мал. 32.3д, с. 153). У різних груп тварин можуть бути додаткові сенсорні системи, характерні лише для них. Так, деяким видам риб притаманне чуття змін електричного поля (акули, скати, химери, морміри та ін.). Багато з них можуть генерувати слабке електричне поле та сприймати його. Така здатність використовується для орієнтування в каламутних водах, пошуку здобичі та комунікації з іншими рибами (мал. 32.4).
1.
спочатку, а як — за певний час? Перенесіть руку в ємність із водою, де температура води 18–20 ºС. Потримайте деякий час. Знову перенесіть руку в гарячу воду. Оцініть ступінь відчуття гарячого в обох
3. Щільно закрийте ніс, затримайте дихання та скуштуйте,
смачнішою?
4. Увімкніть якусь знайому мелодію. Прослухавши
ваше сприймання?
5. Прочитайте опис властивостей сенсорних систем. Установіть, які з них ви досліджували. Зробіть висновок.
Усі сенсорні системи здатні підлаштовувати чутливість сприймання сигналів залежно від сили впливу подразника це адаптація. Їх можна тренувати, щоб розрізняти схожі між собою сигнали. Для всебічного оцінювання предмета чи явища потрібна взаємодія одразу кількох сенсорних систем. Якщо одна із сенсорних систем ушкоджена, інші сенсорні системи працюватимуть так, щоб компенсувати відсутність певного


Органами чуття хребетних тварин є очі, вухо, ніс (ніздрі), шкіра, бічна лінія, вусики, вібриси та інші. Безхребетні тварини мають або подібні органи чуття (очі, нюхові ямки, волоски), або специфічні для них статоцисти, фасеткові (складні) очі, тимпанальні мембрани (слух), орган Джонстона та ін. (схема 18).






адаптації до середовища існування та
життя.
Так, спочатку виникли окремі рецепторні
вони
тілу (мал. 32.6а). Виникнення двобічної симетрії у тварин, головного відділу



(мал. 32.6б). Водночас ускладнювався головний
спеціальними відділами
сенсорної інформації. Надалі
рецепторів і забезпечили
окремого
1.
2.
3.


rnk.com.ua/ 109460
§ 33
Зорова сенсорна система
Поміркуйте й обговоріть
Очі — це органи чуття, через які людина отримує до 80 % інформації про навколишній світ. Навіть незначне погіршення зору помітно позначається на якості життя. Статистичні дані свідчать, що зір українців за останні 10 років значно погіршився,
особливо в молодих людей.
Які основні причини розвитку порушень зору? Як можна
запобігти його погіршенню?
Завдання
Розгляньте шкалу електромагнітного випромінювання (мал. 33.1). Випишіть, яка довжина хвиль відповідає видимому світлу.
(мал. 33.1). Рецептори
лише видимого діапазону, що відповідає кольорам веселки: від фіолетового до червоного. Деякі тварини можуть сприймати ультрафіолет (північні олені, сиворакші, деякі сови, різні метелики, бджоли, скорпіони) та інфрачервоне теплове випромінювання (гримучникові змії, удави, комарі, постільні клопи, деякі кажани, жуки). Ми здатні бачити лише ті об’єкти, від яких відбивається


Мал. 33.3.
від об’єкта відбиваються
хвиль як окремі кольори (мал. 33.2).
Будова зорової сенсорної
Зорова сенсорна система, або
тор, здійснює сприймання
подразників (мал. 33.3).
Будова ока
Очі розташовані в орбітах, що утворені кіст-
ками черепа. Вони забезпечують регулювання, спрямування та заломлення пучка світла





Відкритий мікрофон
Чому деякі предмети на вигляд чорні? Чи існує чорний колір?
яка
світло, створюючи зменшене та перевернуте зображення. Це зображення фокусується за допомогою кришталика на фоторецепторах сітківки ока.


1.
2.
3.
4.
1.
2.
3.
4.
5.





Колбочки це рецепторні клітини, що містять пігменти фотопсини та забезпечують колірний денний зір за системою RGB. У сітківці людини три типи колбочок із різними фотопси-
нами. Вони сприймають, відповідно, червоний (Red), зелений (Green) і синій (Blue) кольори. Найбільша кількість колбочок у жовтій ямці, де в нормі фокусується зображення на сітківку.
Генетичні мутації, що призводять до відсутності пігменту колбочок, спричиняють втрату
здатності розрізняти один (частіше червоний)
або кілька кольорів. Таку особливість людей називають

Для профілактики проблем із зором важлива вчасна професійна діагностика, яку проводить лікар-офтальмолог (мал. 33.8).
Зовнішній шар сітківки містить нервові клітини, які формують аксони зорового нерва. Він
виходить із сітківки в місці, що називається сліпа пляма, оскільки тут немає фоторецепторів. Фокусування променів від об’єктів
цю ділянку сітківки унеможливлює їхнє бачення. Дослідження





Допоміжний апарат ока
апарат ока забезпечує його повноцінну роботу. В умовах наземно-повітряного середовища дуже важливими є слізні залози, що виробляють сльози для зволоження й очищення ока. Вона також містить лізоцим, що знешкоджує бактерії (мал. 33.10). Повіки це складки шкіри, які захищають очі від пилу, розподіляють сльозу й очищують око. Брови запобігають потраплянню

Можна ускладнити навантаження: фокусуватися на трьох-чотирьох різновіддалених об’єктах.
3. Упродовж хвилини робимо рухи очними яблуками:
угору — вниз із максимальною амплітудою;
коловий рух за годинниковою стрілкою
рух за діагоналлю;
рухаємо очі літерою S: спочатку в горизонтальному
положенні, потім — у вертикальному;
зводимо зіниці до перенісся щосили, наблизивши палець до носа. 4. Міцно заплющуємо очі на кілька секунд, потім розплющуємо їх. Повторюємо 8–10 разів.
Під час роботи за комп’ютером слід пам’ятати, що оптимальна відстань до екрана 60–80 см (мал. 33.11). Необхідно частіше кліпати очима. За умов постійної роботи за комп’ютером робіть невелику перерву через кожні 40–60 хв. Коли пересихають очі, використовуйте «штучні сльози». Регулярно виконуйте гімнастику для очей.

1.
2.
3.

4.
5.


Які подразники сприймає слуховий аналізатор?
Якщо швидко помахати рукою чи, утримуючи в руці, зігнути та відпустити лінійку, ми почуємо звук. Виникнення звуку зумовлено механічними коливаннями. Тож звук це механічні коливання частинок середовища (молекул повітря, молекул води або атомів твердого тіла), які поширюються у вигляді хвилі. Його можна порівняти з хвилею, що здіймають уболівальники на стадіоні (мал. 34.1).
Залежно від кількості коливань, які здійснюються за одиницю часу, розрізняють звуки різної частоти. Рецептори вуха людини здатні сприймати звуки в діапазоні частот від 16 до 20000 Гц (Герц одиниця вимірювання частоти коливання. Показує кількість коливань
Мал. 34.1. Поширення механічної хвилі: а — уболівальники на стадіоні — це «молекули

Поміркуйте й обговоріть
Деякі люди мають унікальну особливість: абсолютний слух, що дає змогу їм точно розпізнавати й відтворювати висоту будь-якого звука. За статистикою, її має одна людина з десяти тисяч. Проте в людей, що з дитинства


Мал. 34.2. Діагностика слуху
за допомогою аудіометра
так і ультразвук (собаки), які людина не чує. Вухо людини й тварин сприймає не лише звуки, які йдуть від джерела
чином мозок може відтворювати тривимірну картину світу,
апарати. Переглянь відеоролик про експонат «Звук зубами». Чи зрозуміло тобі, як відбувається
процес передавання звуку, продемонстрований у відео?
Оціни, чи потрібно тобі
додатково попрацювати
з матеріалами з різних
джерел, щоб розібратися
в цьому? Що тебе найбільше
зацікавило в цій темі?

1.
2.
3.
4.
Відео «Звук зубами» rnk.com.ua/110456
черзі закривати
праве вухо. Увімкніть музику на телефоні найтихіше,

Вухо складається з трьох частин: зовнішнього, середнього та внутрішнього (мал. 34.4). Окрім вушної раковини, усі частини вуха розташовані всередині скроневої кістки. Зовнішня й середня частини вуха збирають, спрямовують і посилюють звуки. Внутрішнє вухо містить структури для їхнього сприймання. Зовнішнє вухо складається з вушної раковини та слухового проходу. Вушна раковина збирає й спрямовує звукові хвилі в слуховий прохід трубку, що проводить звуки до барабанної перетинки. У його стінках є залози, які
виділяють вушну сірку, що змащує слуховий прохід і захищає від
Завдання
Проаналізуйте зображені складники слухової сенсорної системи на мал. 34.3. На його основі побудуйте блок-схему слухового аналізатора за принципом, поданим у параграфі 32, мал. 32.1, с. 153. Яку функцію виконує середній мозок, сприймаючи інформацію про звукові сигнали? Яку функцію виконує таламус і нейромережі слухової кори?


закладало» вуха.
перетинка сприймає звукові коливання й передає їх на слухові кісточки (молоточок, коваделко, стремінце). Вони посилюють ці коливання й передають їх на мембрану овального вікна завитки. У внутрішньому вусі розташована

до овального вікна внутрішнього вуха (мал. 34.5). Коливання мембрани овального вікна далі передаються рідині, що заповнює канали завитки. Це спричиняє коливання базальної мембрани, що викликає загинання волосків волоскових клітин, коли вони торкаються покривної мембрани (мал. 34.6). У результаті в рецепторах кортієвого органа виникає збудження, яке передається дендритам присінково-завиткового нерва. Нервові

апарату. Він складається з трьох півколових
і двох мішечків (мал. 34.7).
канали розташовані в трьох різних площинах. Вони заповнені рідиною, на їхніх кінцях є роз-
ширення ампули, де містяться купули із чутливими волосковими клітинами. Внаслідок поворотів або нахилів голови рідина всередині
каналів зміщується, що загинає купулу й волоски рецепторних клітин. Рецептори трьох півколових каналів сприймають обертальні рухи, прискорення та гальмування тіла за
рахунок інерції рідини в них.
У мішечках також розміщені чутливі волоскові клітини. Їхні волоски занурені в желеподібну отолітову мембрану, у якій є «вушні камені»,



Motion sickness occurs when our brain receives incompatible information from different sensory systems (hearing, vision, receptors of joints and muscles). It can happen when we’re riding in a car. Imagine a child sitting in the back seat without being able to see out the window. The child’s inner ear will sense motion, but his or her eyes and body won’t. This creates confusion in the brain. The result may be an upset stomach, cold sweat, fatigue, loss of appetite, or vomiting. What can we do to prevent a car sickness?
1.
2.
3.
4. Вийміть
5.
6.
7.
8.

rnk.com.ua/ 109462

Запахи та смаки
За допомогою запахів ми оцінюємо хімічний склад компонентів середовища. Тобто якість їжі, присутність інших організмів, безпечність речовин і багато іншого. Для оцінки якості їжі необхідний ще й смаковий аналізатор. Так, багато шкідливих речовин є гіркими, а от солоденьке означає наявність вуглеводів найкращого джерела енергії.
Що ж таке смак і запах? Запах
тивне відчуття, що створюється в корі головного мозку після сприймання хеморецепторами молекул органічних чи неорганічних речовин. Смак це теж суб’єктивне відчуття після сприймання хеморецепторами молекул або йонів різних хімічних речовин. Тобто нюхова та смакова сенсорні
аналізатори (мал. 35.1).












Волоски
Смакові

ротової порожнини, щоки та глотки. Лицьовий, язико-глотковий і блукаючий нерви передають інформацію
смакових
у довгастий мозок. Тут локалізується центр слиновидільного рефлексу. Нервовими шляхами ця інформація проводиться далі в таламус проміжного
частку кори головного мозку. Центри формування смаку розташовані в скроневій та тім’яній частках у тісному зв’язку з іншими центрами.
1. Окремі зони язика спеціалізовані
Чутливі







Периферичний відділ нюхового аналізатора містить близько 10 млн спеціалізованих нейронів нюхових рецепторів слизової оболонки верхнього носового ходу. Від них інформація передається нюховими нервами в структури лімбічної системи головного мозку, що аналізують сигнали про запахи (мал. 35.3).
Сенсорна система дотику
Відчуття дотиків, як і нюх, це найдавніше чуття тварин.
Дотикова чутливість людини зумовлена наявністю різних механорецепторів у шкірі (мал. 35.4). Вони сприймають механічні впливи: дотик, тиск і вібрацію. Далі інформація

J Довідка. За допомогою
пропріорецепторів людина навіть із заплющеними очима може виконувати складнокоординовані рухи.
паличку (зубочистку) та зробіть нею дотики до різних ділянок шкіри поверхні руки й передпліччя. Чи в усіх ділянках однаково відчувається дотик? Зробіть висновок про розподіл рецепторів у шкірі.

сильних або ушкоджувальних чинників на структури організму.
1.
2.
3.
3.
4.
5.
6.



rnk.com.ua/ 109463
можуть виявлятися по-різному. За якими критеріями можна
визначити, що в людини
є захворювання саме нервової
системи? Чим захворювання нервової системи
відрізняються від захворювань
інших фізіологічних систем?

Травми
Нормальне функціонування
системи може бути порушене в результаті травм,
єння, інфекцій, стресів та інших факторів. Чи чули ви про струс головного мозку
він головним болем, непритомністю, дезорієнтацією. Ці симптоми виникають тому, що мозок ударяється об черепну коробку зсередини (мал. 36.1). Таке відбувається внаслідок прямого удару в голову або прискореного руху голови з наступним різким уповільненням. Іноді, коли ви довго лежали на боці або сиділи, закинувши ногу на ногу, відчуваєте оніміння, а потім поколювання в руці чи нозі. Це є результатом здавлювання (компресії) нерва, до якого відновлюється
ми. Іноді людині варто просто відпочити, але у тяжких випадках
Серйозним психічним розладом є депресія. Це не просто пригнічений настрій.
Депресію
лікарів.
Профілактика неврологічних захворювань
Профілактика багатьох захворювань нервової системи
життя.
організму
шкідливих звичок тощо (схема





Здійснювати піші прогулянки на свіжому повітрі, організовувати активний відпочинок Уникати

Не вживати алкоголю та наркотиків, не палити





Менінгіт це
головного та спинного мозку, яке починається з різкого підвищення температури, сильного
головного болю, нудоти. Спостерігаються затьмарення свідомості, марення, чутливість
до світла, напруження м’язів потилиці. Тож людина не може нахилити голову вперед (мал. 36.2). Довгостроковими наслідками
можуть бути втрата слуху й зору, порушення мовлення й пам’яті.
Найбільш поширеними збудниками менінгіту є кілька видів бактерій, зокрема менінгокок. Джерелом інфекції може стати людина, хвора на менінгіт, або здоровий носій інфекції. Менінгіт передається повітряно-крапельним шляхом. Перебування в закритих приміщеннях і підвищена вологість сприяють поширенню збудника. Найбільша кількість захворювань простежується в зимово-весняний період. Менінгіт може призвести до смерті й вимагає надання невідкладної медичної допомоги! Проти бактеріальних збудників менінгіту існує ефективне лікування антибіотиками та розроблені вакцини. Кліщовий енцефаліт вірусне захворювання, що передається через укуси іксодових кліщів.
Першими виявами захворювання є лихоманка, головний біль, блювота. Подеколи розвиваються симптоми, як під час менінгіту: затьмарення свідомості, розлади чутливості й рухів тощо.
Коли є ознаки енцефаліту, слід негайно звернутися за медичною допомогою!
Найбільш дієва профілактика від кліщового
енцефаліту вакцинація. Але правильна
поведінка теж може захистити. Тому:
уникайте місць, де можуть










1.
2.
3.
4. Продезінфікувати рану.
5. Відправити




rnk.com.ua/

Гуморальна
Чи багато клітин у вашому
працюють злагоджено чи
бить те, що їй заманеться? Звісно, наш
нізм це «команда», що складається десь із 30·1012 клітин, які мають працювати злагоджено, як єдине ціле або як система.
Як клітини одних тканин і органів «знають», що роблять клітини інших частин організму? Так само, як це робимо ми під час командної роботи, тобто за допомогою особливого міжклітинного спілкування. А що є словами в цій мові міжклітинної комунікації? Це можуть бути молекули різних





Мал.
(«ендо» означає
Гормон
активна речовина, яка виробляється залозою внутрішньої секреції, поширюється через кров і регулює процеси життєдіяльності організму.
За хімічною природою гормони можуть бути різноманітними молекулами: малими молекулами похідними амінокислот (наприклад, адреналін) і похідними холестеролу (наприклад, тестостерон); або пептидами, що складаються з декількох амінокислот (наприклад, вазопресин); чи великими білковими молекулами (наприклад, інсулін). X На рівні


ендокринні захворювання»
Знайдіть інформацію, упорядкуй-


(мал. 37.2, с. 185).
підшлункова,



20,






The hypothalamus is a coordinating center of the endocrine system. It itegrates signals derived from the brain cortex, inner organs, hormone levels, chemical substances in blood, environmental cues such as light and temperature. Then it processes this information and regulates a the pituitary gland, inner organs, body temperature and other physiological processes.


rnk.com.ua/ 109465



шишкоподібне тіло, виробляє мелатонін у темний час доби, коли на сітківку ока не потрапляє світло (мал. 38.1).
Мелатонін регулює добові та сезонні біоритми. Зокрема, він спричиняє посвітління шкіри під зиму, затримує ріст і статеве дозрівання організму. Мелатонін зменшує активність кори головного мозку, знижує рівень стресових
імунітету.
Мал.




Щитоподібна залоза (мал. 38.2а) виробляє три
гормони: тироксин, трийодтиронін
жить від рівня тиреотропного гормону (ТТГ)
гіпофіза.
Молекули гормонів щитоподібної залози містять чотири (тироксин, або Т4) або три атоми Йоду (трийодтиронін, або Т3). Ці гормони прискорюють обмін речовин, збільшують вироблення тепла, забезпечують нормальний ріст і диференціацію клітин тканин. Гормони щитоподібної залози необхідні для нормального здійснення процесів життєдіяльності всіма тканинами й органами організму.
Кальцитонін бере участь в обміні Кальцію
знижує рівень Ca2+ в плазмі крові. Задля цього він блокує розщеплення солей кальцію в кістковій тканині та знижує реабсорбцію катіонів
Кальцію в нефронах.
Паращитоподібні залози (мал. 38.2б)

на сьогодні. Робота
Часто в людей виникає «джетлаг», або десинхроноз (десинхронізація біологічних ритмів). Дізнайтеся, внаслідок чого він виникає та які порушення в організмі відбуваються. Чи стикалися ви з «джетлагом»? Який гормон може допомогти адаптації під час десинхронозу? Що слід зробити для зменшення його наслідків?

Відкладання
Розчинення
Пригадайте основні біологічні ефекти симпатичного відділу
нервової системи на організм
людини й доповніть
перелік функцій адреналіну, який дублює ці ефекти.
Чи обов’язково стрес
пов’язаний із негативними ситуаціями? Наведіть якомога більше випадків, коли у вас чи інших людей виділявся адреналін. Навіщо в цих ситуаціях потрібні його ефекти?


виділення
Кортизол це глюкокортикоїдний гормон, який регулює обмін білків, вуглеводів і жирів. Зокрема, він спричиняє зростання рівня глюкози в крові. Кортизол змінює весь обмін
речовин задля поповнення організмом «сил», щоб подолати стресові реакції та пристосуватися до них. За таких умов він пригнічує запальні й алергічні імунні реакції.
Залози змішаної секреції
Підшлункова залоза виробляє та виділяє
у дванадцятипалу кишку травний сік (пригадайте його роль у травленні) це зовнішня (екзокринна) секреція. У її тканині містяться скупчення клітин,




rnk.com.ua/ 109466

Антигени та імунітет
Організм як єдина система для свого існування має підтримувати свою цілісність та індивідуальність.
У кожного окремого організму є свої унікальні білки, які кодуються його генами. Ці білки, наче штрих-код, визначають приналежність клітин до певного організму чи тканини. На речовини, які мають ознаки генетичної відмінності (антигени), може виникати імунна
відповідь. Імунна система виробляє проти них «зброю» білки імуноглобуліни (антитіла).
Антигенами найчастіше виступають білки, що належать іншим організмам або є зміненими
в результаті мутацій власних білків.
Відмінності між генами різних людей зумовлюють різницю в білках і, відповідно, в ознаках організму. Якщо в організмі з’являються, наприклад, антигени вірусів або антигени ракових клітин (змінені власні), то їх треба знешкодити й знищити, щоб
цілісність та індивідуальність
територією імперії), він створив мобільні корпуси. Такі групи мали тимчасовий характер і організовувалися спеціально для конкретної кампанії, після якої їх розпускали. Чому такий розподіл на бар’єрні кордони, війська загального та спеціального призначення,








більшість антигенів, зокрема, і свої. Щоб не нашкодити організму, слід відсортувати лише ті клітини, що розпізнають
ється в тимусі.
(загруднинна,
вилочкова залоза) центральний орган імунної системи, який активно працює в людей
(мал. 39.1). У
відбувається розмноження, дозрівання та добір, або селекція, Т-лімфоцитів
є лімфатичні вузли, селезінка і скупчення лімфоїдної тканини в слизових оболонках, наприклад, носоглотки (мигдалики, аденоїди), тонкої кишки (пеєрові бляшки) та апендиксу. Тут «живуть» і працюють імунні клітини (лейкоцити). У цих органах вони здійснюють імунну відповідь: розпізнають і знешкоджують антигени.
Види імунітету
Якщо мікроорганізми подолали першу лінію «укріплених кордонів» організму слизові оболонки та шкіру, то на них чекають «війська загального призначення» «гарнізони» лейкоцитів. До того ж імунні клітини та деякі інші клітини організму виробляють «хімічну зброю» спеціальні захисні білки (лізоцим, інтерферони та ін.). Це вроджений імунітет, який здатний знешкодити більшість антигенів (схема 21).
Якщо ж друга лінія захисту не впоралася, то долучаються «війська спеціального призначення» Т-лімфоцити та В-лімфоцити, що забезпечують адаптивний імунітет, чітко спрямований саме проти конкретних антигенів.
3 2 1

с. 195 і текстом підручника, дайте відповіді на запитання. А) Чим відрізняються вроджений і адаптивний імунітети?
Б) Які клітини забезпечують
клітинний імунітет?
В) Які молекули забезпечують гуморальний імунітет?



Вроджений імунітет За допомогою
рій,
клітини та перетравлюють їх (мал. 39.2). У місці роботи фагоцитів розвивається реакція запалення, куди мігрують на допомогу нові фагоцити. У результаті боротьби нейтрофіли гинуть разом із бактеріями і формують гній. Серед лейкоцитів є особливі клітини природ-
зупиняють поділи інфікованих чи ракових клітин і запускають їхню загибель (мал. 39.3).
Здебільшого механізмів вродженого імунітету
цілком достатньо, щоб подолати більшість інфекцій і стримувати утворення ракових клітин. Вроджений імунітет забезпечує також
несприйнятливість людини до інфекційних захворювань, що
1.

та захисні білки (інтерферони, лізоцим). Характерні для


rnk.com.ua/ 108584

клітин. Однак жодні механізми не ідеальні, а патогенні
їх долати. Для повноцінного захисту організму необхідна високоспецифічна й прицільна «зброя», спрямована безпосередньо проти конкретного антигена, збудника інфекції чи ракової клітини. Це адаптивний імунітет.
Гуморальний адаптивний імунітет У лімфовузлах і селезінці розташовані численні В-лімфоцити. Кожен із них має унікальні рецептори на поверхні клітини. Рецептори одного В-лімфоцита можуть з’єднуватися лише
в організм, циркулює рідинами внутрішнього середовища




Антитіла, або імуноглобуліни (скор. Ig), це складні білки, які специфічно розпізнають і зв’язують антигени. Існує кілька різновидів антитіл: імуноглобулін М (IgM), імуноглобулін G (IgG), імуноглобулін Е (IgE) та інші (мал. 40.3). Після з’єднання антигена з антитілом антиген не здатний завдавати шкоди. Надалі клітини-макрофаги розпізнають комплекси «антиген антитіло», поглинають і руйнують їх.
Після одужання антитіла поступово руйнуються й зникають, але в організмі тривалий час
залишається невелика кількість В-лімфоцитів, що «пам’ятають», як виробляти антитіла саме проти цього антигена. Якщо антиген повернеться, то ці клітини дуже швидко активуються й знову напрацюють потрібні антитіла.
Клітинний адаптивний імунітет
Часто неможливо просто так нейтралізувати антигени чи їхніх носіїв, адже вони можуть бути всередині клітин організму (віруси, сальмонели, малярійний плазмодій). Уражені внутрішніми паразитами або ракові клітини необхідно знищити за допомогою спеціальних клітин.
Для цього іс нують Т- лімфоцити-кілери (мал. 40.4).


сироватки
нітету в боротьбі із захворюваннями? Двома основними шляхами: специфічна профілактика інфекцій та деяких вірусів і бактерій, що можуть викликати рак (вакцини) та лікування захворювань (сироватки). Вакцинація, або щеплення, це введення в організм вакцини препарату, що містить
Проаналізуйте інформацію
про склад кількох вакцин (наприклад, від грипу, коронавірусу, правця) та з’ясуйте, що є антигеном у цих вакцинах.
Знайдіть інформацію
й виконайте завдання
Проти яких захворювань існують лікувальні сироватки?
Чи є альтернатива сироваткам? Підготуйте про це тезову доповідь.


rnk.com.ua/
та
розвитку серйозних захворювань ендокринної системи (схема 22).
Серед ендокринних захворювань відомі такі, як-от: гігантизм, гіпофізарна
карликовість, акромегалія, мікседема, хвороба Грейвса, кретинізм, діабет та інші.

Змоделюйте
гіперфункції та гіпофункції цієї залози (гормону) в дітей. Як можна
допомогти дитині в разі
гіпофункції цієї залози?
Ідентифікуйте всі типи
ендокринних розладів, які ви описали, за допомогою
додаткових джерел інформації.
Підготуйте коротку доповідь з ілюстраціями та поясненнями.


сімейної
звернулася жінка 38 років із загальними скаргами: м’язова слабкість, втрата ваги, часта тахікардія, біль у животі та розлади травлення. Під час огляду лікарка помітила специфічне потемніння слизових оболонок і гіперпігментацію шкіри пацієнтки та скерувала її до ендокринолога.
волосся та ранній початок посивіння.
Ситуація №2. Пацієнтка скаржиться на прогресивну втрату маси тіла, пітливість, тахікардію, аритмію, тремтіння кінцівок та екзофтальм виряченість очей (як зображено на малюнку).
Ситуація №3. На черговому огляді лікар помітив














2.
3.

rnk.com.ua/ 109469

Різноманітність
що на початку еволюції живі організми розмножувалися лише нестатевим шляхом. На певному етапі розвитку живого з’явилося статеве розмноження. Сьогодні на планеті більшість видів
або розмножується статевим шляхом, або використовує життєвий цикл, у якому спостерігається чергування статевого і нестатевого
поколінь.
Завдяки яким перевагам статеве розмноження стало таким поширеним?

женню. Під час розмноження спостерігаються такі властивості живого, як спадковість і мінливість. Спадковість це здатність організмів передавати нащадкам свої ознаки та властивості, а мінливість забезпечує набуття нових ознак і властивостей, існування в різних формах і варіаціях.
(самовідтворення, репродукція)





клітина. У мейозі
на одне подвоєння ДНК припадає два послідов-
ні поділи клітини. Завдяки цьому формуються чотири клітини, у яких кількість ДНК вдвічі менша, ніж у материнської клітини (мал. 42.2).
На організмовому рівні існують дві основні форми розмноження. Це статеве розмноження (мал. 42.3, с. 208), коли розмноження відбувається за допомогою спеціалізованих статевих клітин гамет, і нестатеве розмноження, під час якого гамети не формуються, а розмноження відбувається за участю нестатевих клітин (їх іще називають соматичними). У багатьох
видів спостерігається життєвий цикл, у якому відбувається чергування статевого й нестатевого поколінь.
Статеве












обов’язково про них піклуються. Ці дві репродуктивні стратегії мають назви r-стратегія та K-стратегія (таблиця
Ріст і розвиток є такими ж фундаментальними властивостями живого, як і розмноження.
Індивідуальний розвиток організму має назву онтогенез. Онтогенез різних груп організмів
охоплює певні особливості, які визначаються різними факторами. Одним із таких факторів є спосіб розмноження.
Для організмів, які розмножуються статевим шляхом, онтогенез починається з моменту утворення зиготи й триває до природної смерті Таблиця 11. Характеристика




Онтогенез (від грец. ontos — те, що існує; істота + genesis — походження, народження) — індивідуальний розвиток особини від її зародження до смерті.
Ембріональний період триває від утворення зиготи до народження або виходу з оболонок яйця. Постембріональний період починається з наро-
статевої зрілості. Непрямий розвиток, або метаморфоз, відбувається із суттєвими змінами (перетворенням) будови організму. За непрямого розвитку організм, що з’явився (личинка), суттєво відрізняється за будовою від дорослої особини. Личинка може мати специфічні органи, які із часом замінюються органами, притаманними дорослому організму.
Метаморфоз (від грец. metamоrphosis — перетворення) — суттєве перетворення будови




rnk.com.ua/ 109470
диморфізм» (від лат. di — два, morphe — форма), тобто відмінності між
самцями і самицями одного
й того самого біологічного
виду за їхніми розмірами
й анатомічною будовою.
Різняться й статеві клітини, які формують чоловічий
і жіночий організми.
Як ви вважаєте, чому виникає
така різниця? Чи є такі відмінності адаптивними? Репродуктивна
дитини в
лактації (період, у якому молочні залози виробляють грудне молоко для годування новонародженого немовляти).
Оскільки роль чоловічого й жіночого організмів щодо нащадків відрізняється, їхні статеві системи побудовані по-різному й по-різному функціонують.
Головним органом жіночої статевої системи є парні залози, у яких утворюються яйцеклітини й виробляються статеві гормони.
ді мають яйцеподібну форму. Яєчка виконують в організмі дві важливі функції: утворення чоловічих статевих клітин (сперматозоїдів) і синтез статевих гормонів. Розташовані яєчка в шкірному мішечку мошонці (укр.: калитка). Це пов’язане з тим, що для дозрівання
сперматозоїдів потрібна температура, нижча від тієї, що є всередині тіла. У
температура нижча, що сприяє нормальному розвитку гамет. Складаються яєчка зі звивистих сім’яних канальців, у яких утворюються сперматозоїди. Потім сперматозоїди надходять до придатків яєчок, саме там




статевих органах чоловіка й жінки відбувається гаметогенез: у жіночих яєчниках овогенез, а в чоловічих сперматогенез. Процес овогенезу відбувається в яєчниках і складається з трьох періодів: розмноження, росту і дозрівання. У періоді розмноження диплоїдні клітини діляться шляхом мітозу, утворюючи диплоїдні овоцити. У

У результаті мейозу утворюється чотири гаплоїдні сперматиди, які всі отримали однакову частину цитоплазми. Вони перетворюються на зрілі сперматозоїди, які є невеличкими за розміром і не мають запасу поживних речовин. Сперматозоїди містять джгутик і можуть швидко рухатися (мал. 43.2).
Будова статевих клітин
Статеві клітини виконують важливу функцію передачі інформації від покоління до покоління. Тому їхня будова сприяє забезпеченню запліднення, формування


Половина сперматозоїдів містить Х-хромосому, половина — Y-хромосому.
Усі нормальні сперматозоїди мають рівні
шанси на запліднення.
Користуючись текстом і малюнком,
дайте відповідь на запитання: «Від кого залежить стать майбутньої дитини: від батька чи від матері?».
Допоможе вам це з’ясувати скрайбінг «Хлопчик чи дівчинка?».



розчиняє оболонки яйцеклітини для проникнення всередину. Сперматозоїд має достатню кількість мітохондрій, які забезпечують його активний рух. Цитоплазми в сперматозоїдів обмаль, бо основною функцією цих клітин


3.
4.
5.
6.
1.
2.
3.
4. Навіщо парна
5. Знайдіть інформацію

rnk.com.ua/ 109471

Онтогенез

Перший
до народження.
Другий період постембріональний (або післязародковий). Він триває від народження до набуття організмом
множення.
Третій період репродуктивний
Новий організм виникає завдяки процесу запліднення, тобто злиттю гамет і утворенню зиготи. Зигота містить подвійний (диплоїдний) набір хромосом, тому майбутній організм буде мати особливу комбінацію материнських і батьківських ознак (мал. 44.1). У цьому виявляється мінливість. Однак нащадки одночасно будуть схожими на обох батьків. У цьому виявляється спадковість (мал. 44.2).
Після першого поділу зиготи з’являються дві клітини, які мають назву бластомери. Бластомери це клітини, що утворюються в результаті дроблення заплідненого яйця, тобто зиготи. Від клітин зародка наступних стадій розвитку, які відбуваються після завершення стадії дроблення, бластомери відрізняються тим, що вони є більшими за розмірами й однаковими між собою.
Спочатку бластомерів лише дві клітини, які утворилися після першого поділу зиготи, потім клітини здійснюють поділ, їх стає 4, 8, 16, 32 й далі, допоки клітини зародка є морфологічно подібними. У ссавців після стадії 16 бластомерів формується морула, клітини якої вже не є
однаковими, вони відрізняються.

Дроблення — серія поділів зиготи, яка настає після запліднення,


Мал. 44.4.




Завершується ембріональний
ням тканин (гістогенез)
органів (органогенез) (мал. 44.5).
індивідуального
ного розвитку, якому передують

періоду онтогенезу.
Плід
Онтогенез
індивідуального розвитку організму. Ембріональний період відбувається
в материнському організмі
й триває від утворення
зиготи до народження. Постембріональний період
супроводжується ростом, суттєвими анатомічними, фізіологічними, психологічними

5.

rnk.com.ua/ 109472

Репродуктивне здоров’я
Репродуктивне здоров’я є важливим складником здоров’я людини. Ідеться не просто
про відсутність хвороб статевої системи. Ідеться про стан фізичного, емоційного, інтелектуального й соціального благополуччя. Для збереження репродуктивного здоров’я
потрібні знання й певна культура статевих стосунків.
Репродуктивне здоров’я людини це насамперед нормальне функціонування органів її статевої системи. Хвороби статевої системи можуть виникати через порушення роботи ендокринної системи, хронічні захворювання, інфекційні процеси. Крім того, репродуктивне здоров’я залежить від способу життя та наявності корисних і шкідливих звичок.
що передаються статевим шляхом (скорочено — ЗПСШ). Насправді репродуктивне здоров’я є багатокомпонентним: це сексуальне здоров’я, планування сім’ї та безпечне, відповідальне батьківство й материнство. Але про останнє в цих розмовах майже не згадується. Як ви вважаєте, чому?

Відмова від шкідливих
звичок, уникнення сильних стресів, повноцінний сон
Відкритий мікрофон
Користуючись схемою вгорі, розкажіть про фактори, які
репродуктивне здоров’я,
Здоровий спосіб
життя, збалансоване
харчування, помірні фізичні навантаження
впливу
Утримання від ранніх статевих стосунків, уміння
до гінеколога (а) й андролога (б) є
соціальну компоненту. Соціальна зрілість необхідний етап розвитку особистості.
Люди мають дозріти біологічно, психологічно й соціально, щоб вони могли створити сім’ю, виховувати дітей, нести відповідальність одне за одного.
Які фахівці / фахівчині можуть допомогти, якщо в людей виникають певні проблеми з репродуктивним здоров’ям? Існують медичні науки, спеціальності й галузі медицини, Мал. 45.1. Регулярні візити
важливими для збереження репродуктивного здоров’я та профілактики захворювань


Споживання алкоголю, наркотиків, відсутність
аналізу негативних
наслідків власних дій
Шкідливі звички батьків, які згодом впливають на фертильність нащадків
Гормональні порушення або ендокринні захворювання (надлишок або
Негативні чинники соціального середовища (низький рівень життя, безробіття тощо)
Ранній початок статевого життя, неправильне
або недостатнє інформування про способи й методи профілактики небажаної вагітності
Несприятливий для здоров’я спосіб життя, наявність стресів, гіподинамії, незбалансоване харчування (нестача вітамінів тощо)
які вивчають і лікують саме репродуктивну систему.
Чоловіки можуть звертатися до андролога, лікаря, який займається проблемами чоловічої репродуктивної системи. Жінки можуть проконсультуватися й лікуватися в гінеколога (мал. 45.1). А ще існує така дисципліна, яка зветься акушерство. Вона займається вивченням вагітності, пологів і післяпологового періоду, їхньої фізіології й патології та методів допомоги вагітним і породіллям.
Андрологія — медична спеціальність, яка займається чоловічим здоров’ям, зокрема, проблемами чоловічої репродуктивної системи та урологічними проблемами, що властиві лише чоловікам.
Гінекологія — галузь медицини, яка займається лікуванням захворювань жіночої репродуктивної системи, що властиві лише жінкам.
різних збудників: вірусів, бактерій, одноклітинних і багатоклітинних паразитів. До того ж людина може одночасно хворіти кількома ЗПСШ одночасно (мал. 45.2; схема 23).
Найпоширенішими ЗПСШ є такі захворювання: сифіліс, гонорея, хламідіоз і трихомоніаз. На жаль, ці інфекції








2.
3.


Поміркуйте й обговоріть ситуацію
Пригадайте, які фізичні
риси відрізняють людину від перших приматів.
Таблиця 12. Таксономічна класифікація людини
Домен Еукаріоти (Eukaryota)
Царство Тварини (Animalia)
Тип Хордові (Chordata)
Підтип Хребетні (Vertebrata)
Клас Ссавці (Mammalia)
Ряд Примати (Primates)
Родина Гомініди (Hominidae)
Рід Люди (Homo)
Вид Людина розумна (Homo sapiens)
Антропогенез Біологічний
австралопітеками та ще кількома вимерлими видами, люди формують родину Гомініди. У роді Люди сучасна людина є єдиним видом, який зараз існує (див. таблицю 12); інші види, як-от Людина вміла або Людина неандертальська, є вимерлими. Антропогенез — це процес походження та еволюції людини як біологічного виду. Реконструкцією еволюції
а 6–7 млн років тому сформувалась лінія, що веде до людини (мал. 46.1). Виникнення людиноподібних пов’язують зі змінами клімату, який став засушливим. Скоротилися площі тропічних лісів, і частина гомінід, до яких належали й наші предки, були змушені вийти в савани. Життя на відкритих просторах дало поштовх для виникнення нових адаптацій, зокрема, прямоходіння.
Першим із відомих науці видів, що переміщувався на двох ногах, був сахелантроп, який жив в Африці 7 млн років тому. Прямоходіння було властиве й австралопітекам, які існували в
4–2 млн років тому (мал. 46.2, с.














(мал. 46.3). Ці
харчуватися падаллю великих тварин, а свої кам’яні знаряддя використовували для обробки туш і
скрібання
працююча еволюціонувала
берзьку (Homo heidelbergensis), яка поширилася в Африці та за її межами. Людину
гейдельберзьку розглядають як одного з предків, спільних для неандертальців, денисівців і сучасної людини.
Людина неандертальська (Homo neanderthalensis) виникла 450–350 тис. років тому. Назва
походить від долини Неандерталь у Німеччині.
Мешкали неандертальці в Європі та Західній Азії. Неандертальці адаптувалися до холодного
клімату. Вони були невисокими (155–165 см),
мали міцні широкі кістки, циліндричну грудну
клітку й відносно короткі кінцівки, широкий
ніс для зігрівання повітря, світлу шкіру й волосся. Об’єм мозку в неандертальців становив 1300–1600 см3 (мал. 46.4).
Неандертальці займалися полюванням і збиран-
ням, жили у великих групах і користувалися мовою, можливо, жестовою. Вони виготовляли складні знаряддя (списи, сокири та ін.), влаштовували прості укриття з гілок і кісток тварин. А ще добували й використовували вогонь, створювали простий одяг, збирали лікарські рослини, піклувалися про старих і хворих. У неандертальців було символічне мислення й початкове мистецтво. Про це свідчать наскельні малюнки, прикраси з пір’я та мушель.
Приблизно 35–40 тис. років тому неандертальці зникли. Причини їхнього вимирання не з’ясовані. Можливо, вони пов’язані з конкуренцією із сучасними людьми або змінами в навколишньому середовищі.
Людина розумна (Homo sapiens) виникла в Африці понад 200 тис. років тому й поширилася іншими континентами. Ранніх представників

Мал. 46.4. Неандерталець

Робота в парі

J
Довідка. Великий мозок
потребує більше часу
для розвитку, і в людини
подовжилося дитинство — тобто період навчання
й набуття життєвого досвіду.
Для порівняння, павіан дорослішає в 6–8 років, шимпанзе — у 10–12 років.
Індивідуальна робота
Користуючись мал. 46.7, простежте, як змінювалися головний мозок і форма
черепа. Назвіть архаїчні
риси черепа Людини
прямоходячої порівняно
з Людиною розумною.
Якими є особливості черепа
Людини розумної порівняно
з попередніми видами?

позначено час (років тому)
(мал. 46.5 , с. 231), з’явилися вироби з кісток і рогів, поширилися
розвинене мовлення. Поступово Людина розумна розселилася всією планетою (мал. 46.6).
Основні риси
Формування людини пов’язане з низкою анатомічних змін. Ідеться про розвиток прямоходіння (біпедія), збільшення та розвиток мозку (енцефалізація), розвиток хапальної кисті. Крім того, відбулося зменшення щелеп і збільшення мозкового відділу черепа, зменшення розміру ікл та волосяного покриву.



Результатом
високий інтелект і здатність до мовлення. Це сприяло високому рівню
життю у великих групах, обміну інформацією, передачі досвіду від поколінь
дяки розвиненому мозку Людина розумна опанувала майже всі території, досягла технологічного прогресу
сучасної людини
Еволюція людини триває й останні

великої кількості
водів у раціоні. Здатність пити цільне молоко в дорослому віці з’явилася лише 5 тис. років тому. Протягом тисячоліть люди набували
стійкості до інфекцій: туберкульозу, малярії, чуми, холери. Натомість
ції, набуті нашими



rnk.com.ua/ 109474
мовлення, уміння виготовляти
та використовувати знаряддя
праці, високий ступінь розвитку матеріальної
й нематеріальної культури.
Які біологічні особливості виду
Homo sapiens дали йому
змогу досягнути такої складної
поведінки, уміння опановувати
природне середовище
й будувати рукотворний світ?
відображати довкілля у вигляді відчуттів, уявлень, думок, понять, теорій, вольових дій тощо (мал. 47.1). Саме кора відіграє ключову роль у виконанні мозком таких функцій, як-от пам’ять, увага, сприймання, мислення, мовлення, свідомість.
Вища нервова діяльність (ВНД) — це функція вищих відділів головного мозку, яка формує складну поведінку і психічну діяльність. ВНД забезпечує найефективнішу взаємодію організму з навколишнім

Мал. 47.1.
Основними нервовими процесами, що
чують вищу нервову діяльність,
й гальмування. Збудження це підвищення активності нейронів, яке виникає в
центрах і поширюється через
у вигляді електричних імпульсів. Гальмування ж приводить до пригнічення
і активність внутрішніх процесів різна. Типи вищої нервової
Нервова система характеризується трьома властивостями: силою, урівноваженістю
ливістю. Сила нервової системи виявляється в стійкості до тривалого впливу подразника, як збудливого типу, так і того, що загальмовує. Урівноваженість
співвідношенням
Урівноважений
Рухливий
Сангвінік (жвавий тип)
Схема 24. Типи ВНС
Неврівноважений
Інертний
Флегматик (спокійний тип)
Холерик (нестримний тип)
Меланхолік (слабкий тип)

темпераменту.
цьому тесті темпераменти класифіковані
протягом життя (схеми 25, 26). Умовні рефлекси формуються на основі безумовних (таблиця 13, с. 238). Для формування умовного рефлексу потрібна одночасна дія безумовного (наприклад, лимон) і нейтрального (слово «лимон») подразників. Через час на пред’явлення лише нейтрального подразника також буде виявлятися реакція (слиновиділення).
Безумовний рефлекс — це спадково
закріплена форма реагування на певний
подразник, яка здійснюється за участю спинного мозку або стовбура головного мозку.
Умовний рефлекс — це набута пристосувальна реакція організму, що формується на базі
безумовних рефлексів за участю кори головного мозку.
Завдяки комплексу безумовних рефлексів


і розмноження.
Інстинкт — сукупність вроджених складних
актів поведінки, що виникають у живих організмів як реакція
подразнення.
У людини інстинктивна поведінка може виявлятися через базові вроджені потреби в безпеці, їжі, воді, сні тощо. Людина живе в соціумі, тож її інстинктивна поведінка може змінюватися під дією соціокультурних впливів.
Умовний стимул: звучить слово «лимон» Безумовний стимул: їжа Безумовна реакція: слиновиділення

Умовна реакція: слиновиділення


Анімація «Рефлекси людини» rnk.com.ua/109797
умов середовища Можуть об’єднуватися й утворювати
автомобілем, в’язання тощо)
Таблиця 13. Характеристики
і умовних рефлексів
Опорні точки
Основною формою діяльності нервової системи є рефлекси, які бувають безумовними —
спадковими, й умовними, що набуваються організмом протягом життя. Завдяки комплексу безумовних
рефлексів формуються інстинкти, які є спадковими адаптивними формами поведінки, спрямованими на задоволення базових потреб організму.
Міжпівкульна функціональна асиметрія
Ліва півкуля Права півкуля Обробляє вербальну
інформацію, забезпечує здатність до письма й читання
інформацію, розпізнає емоції Розуміє лише буквальне


rnk.com.ua/
Організми тварин і людини перебувають у різноманітних зв’язках із навколишнім середовищем. У їхньому головному мозку виникає система нервових процесів, які забезпечують сприймання й переробку сигналів, що надходять із довкілля. Відображення в мозку дійсності у формі відчуттів учені називають
першою сигнальною системою. Завдяки першій сигнальній системі в організмі формуються умовні рефлекси на різноманітні фактори навколишнього середовища.
Перша сигнальна система — це сукупність нервових процесів, які сприймають дійсність через реальні стимули
тощо).
сигнальна


відчуттів, уявлень, вражень, але й у формі особливих умовних знаків слів. Слова стали «сигналами сигналів» і основою другої сигнальної системи.
Друга сигнальна система — це сукупність нервових процесів, які сприймають дійсність
через слова й позначені ними поняття (тобто через уявні стимули). Перша сигнальна система відображає
системі в представників виду Homo sapiens з’явилася мова система особливих знаків і засобів спілкування між людьми за допомогою слів. Мова як система ефективної комунікації стала одним із найважливіших здобутків людства. Мова є суспільним явищем, надбанням, найважливішим засобом формування людських стосунків. Саме мова дає змогу отримувати, зберігати й передавати інформацію, спілкуватися, навчатися, розвиватися, описувати свої
рі, мармурі, граніті тощо.
сприймати зором. Існує жестова мова вид спеціального письма, який дає змогу позначати слова, а також літери алфавіту певними жестами. Здатність вивчити мову дитина має від народження. Процес навчання починається вже з 5–7 місяців першого року життя і триває
десь до 5–6 років. Дитина може опанувати будь-яку мову, якою розмовляє оточення. Однак мова формується лише в соціумі, під час спілкування з іншими людьми. Якщо дитина ізольована від людського оточення, здатність вивчити мову не може бути реалізованою.
Навчання й пам’ять Розвиток мовлення й мови супроводжувався розвитком мислення. Мислення
яка дає змогу уявити та висловити своє ставлення до предметів і явищ за
Навчання є способом накопичення індивідуального досвіду в процесі взаємодії людини
з її соціальним і культурним середовищем. Завдяки цьому люди накопичують знання
узагальнений досвід людства, виражений у фактах, поняттях, теоріях. У такий спосіб
людина пізнає навколишній світ і набуває
нових форм поведінки. Свідоме застосування
знань для виконання різних форм діяльності в різних





протягом життя. Пам’ять — це психофізіологічний
на), за тривалістю (сенсорна, короткочасна, довгочасна, оперативна), за способом запам’ятовування (мимовільна та довільна). Вивчені види відтворення пам’яті є показником міцності запам’ятовування (упізнавання, згадування, пригадування). Були також визначені індивідуальні особливості пам’яті (швидкість, точність, міцність запам’ятовування та
ність до відтворення). Крім пам’яті,




rnk.com.ua/

Психофізіологічні особливості індивідуальності людини
Якщо в нас запитують про якусь людину: «Яка ж вона?», то ми даємо відповідь, називаючи її особливості, які виявляються в її діяльності та поведінці. Наприклад, вона емоційна й добра, рішуча й весела, упевнена й спокійна. Ми говоримо про риси, або психологічні особливості, які відрізняють соціальний та індивідуальний стилі поведінки людини. У цьому контексті йдеться про риси характеру.
Характер, фактично, є поєднанням вроджених особливостей нервової системи з набутими впродовж життя індивідуальними рисами й реакціями людини.
Становлення характеру зумовлене обставинами й ситуаціями, у які потрапляє людина. Цей досвід сприяє її навчанню й вихованню, роблячи її саме такою, яка вона є. Але людина
темперамент, характер
здібності»?
Неврастенічний тип
Виявляє домінування хворобливого самопочуття, подразливості, підвищеної втомлюваності
Тривожний тип Виявляє надмірну чутливість, боязливість, розгубленість, уразливість, у всьому вбачає небезпеку
Схема
У ставленні до справи: працелюбство, лінь, акуратність, безвідповідальність, організованість, сумлінність, працьовитість, ініціативність, пасивність
Педантичний тип Виявляється в крайньому формалізмі, у дотриманні «букви» документа, хоча це шкодить справі
імпульсивним, конфліктним, категоричним, підозрілим
У ставленні до власності, об’єктів навколишнього світу: працелюбство, лінь, акуратність, відповідальність, організованість, щедрість, жадібність, дбайливість, марнотратство, акуратність, неохайність
здатність до пізнання, розуміння, навчання та розв’язання проблем.
Інтелект є розумовою здатністю людини, яка характеризується здібностями до навчання й міркування, наявним інформаційним потенціалом знань, умінням бачити й розв’язувати проблеми. Інтелект забезпечує здобуття, розуміння, збереження та застосування різноманітних знань, виявляється в логічному й абстрактному мисленні, креативності. Інтелект поширюється на емоційне розуміння, соціальні взаємодії, ідеться про так званий «здоровий глузд».
Воля — це здатність особистості свідомо керувати своїми
Важливим складником характеру є воля. Людина із сильною волею є самостійною, непохитною, такою,
несамостійною,
Сон і його значення
Під час сну наша нервова


Забезпечується

скелетних
Окрім того, спостерігаються швидкі рухи
скорочення
мускулатури, рухи пальців. Іноді людина навіть починає говорити. У цю фазу вона бачить сновидіння і її
розбудити, бо зростає
стадії від 20 до 30 хвилин. Швидкий сон становить 20–25 % від усього сну. У перших циклах на початку сну переважає повільний сон, а періоди швидкого сну дуже короткі: від 10 до 15 хв. А ось у другу половину ночі повільний сон


Біосоціальна сутність людини
Людина має певні психофізіологічні особливості, які дають їй змогу формувати складні соціальні стосунки й різноманітний культурний простір. Соціальна сутність людини виявляється в способі життя, у використанні такої унікальної системи комунікації, як мова, різноманітті способів діяльності, створенні рукотворного світу. Біологічні умови соціальності визначаються
генотипом і є спадковими. А сама соціальна сутність формується завдяки спілкуванню з іншими людьми, навчанню й вихованню в людському суспільстві. У цьому процесі провідну
роль відіграють мова, розумова діяльність і праця. Люди мають усвідомлене ставлення до природи й соціуму, уміють ставити мету, знаходити методи її досягнення й передбача-
ти результати власної діяльності. Здатність до цілепокладання це специфічна людська особливість,

Чи погоджуєтеся ви з його думкою? Як ви вважаєте, чому
з усіх людських цінностей він обрав саме моральність? Чому людський світогляд має бути екологічним?
пов’язана з мовою, абстрактним мисленням, світоглядом, самоконтролем своєї поведінки й діяльності. Людина не лише пізнає навколишній світ, вона його активно змінює. Засновник Української академії наук академік В. І. Вернадський вважав, що людська діяльність суттєво впливає на біосферу. Частину Землі й навколопланетного простору, у якому


змогу завдяки праці цілеспрямовано перетворювати планету, світ навколо і саму себе. Життя
суспільстві
Крім біологічної еволюції виду Homo sapiens, відбувається і його соціальна еволюція розвиток суспільства від початкових форм до більш складних. Саме соціалізація забезпечує розвиток культури, правил етикету тощо. Механізм
Маргарет
поставила своїм студентам і студенткам таке питання: «Що б ви обрали першою ознакою цивілізації?». Студенти відповіли, що це глиняні горщики з першими візерунками, заточені кам’яні різці, рибальські гачки. Але Маргарет не погодилася з ними, вона вважала, що першою ознакою цивілізації в стародавній
культурі є такий археологічний експонат, як людська стегнова кістка, що була зламана, а потім зрослася.
Маргарет Мід пояснила: «Коли жива істота в царстві тварин ламає ногу, то вона помирає.
Кістка зростається досить довго, тому тварина
не має шансів вижити. Стегнова кістка, яка
була зламана, а потім зрослася, це доказ цивілізації, адже хтось побачив
людини, пожалів її, доглядав її, перев’язував рани, напував і годував, допоки вона не одужає та не підведеться на ноги. Допомагати іншій людині під час хвороби або іншого тяжкого
періоду життя це і є той вчинок, із якого
починається цивілізація».
Перший крок до цивілізації це акт людського співчуття: не розглядати людину як ресурс, а ставитися до неї як до цінності. Це перший вияв власної, суто людської, біосоціальності. Наступні кроки


rnk.com.ua/ 111138

Термінологічний словник
А
Авітаміноз — порушення, що виникає через
відсутність окремих вітамінів.
Акцентуації характеру — надмірно посилені
окремі риси характеру.
Анатомія — наука, яка вивчає форму й будову
організму та окремих органів.
Антропогенез — процес походження та еволюції людини як біологічного виду.
Артеріальна кров — кров, збагачена киснем. Має яскраво-червоний колір.
Артеріальний тиск — тиск, який кров чинить
на стінки артерій.
Артерії — великі судини, якими кров рухається від серця до всіх органів тіла. Б
Біосоціальна природа людини — особливості, за якими відрізняється людина від інших організмів і які формуються завдяки впливу суспільства.
Гіпервітаміноз
окремих вітамінів.
Гіповітаміноз — порушення, яке
Гомеостаз — відносна постійність умов внутрішнього середовища організму. Д Дихання
Живлення
середовища речовин та енергії для життєдіяльності.
структурна одиниця скелета. Клітина — елементарна структурна
Метаболізм
сукупність усіх хімічних реакцій у клітинах організму,
Н
Нерви — скупчення відростків нервових клітин
Фізіологічна
Характер

§ 21.
§ 23.
§ 24.

дітей» Редактор Т. М. Мишиньова. Технічний редактор А. В. Пліско.
Художнє оформлення В. І. Труфена, Т. В. Задорожної. Комп’ютерна верстка О. Л. Піковець. Коректор Н. В. Красна.
Підписано до друку 25.05.2025. Формат 84×108/16. Папір офсетний. Гарнітура Шкільна. Друк офсетний. Ум. друк. арк. 26,88. Обл.-вид. арк. 23,00. Наклад 60 442 пр. Зам. № 10904-2025.
ТОВ Видавництво «Ранок», пр. Незалежності, 5, Харків, 61022; вул. Деревлянська, 13, Київ, 04119. E-mail: office@ranok.com.ua
Свідоцтво суб’єкта видавничої справи ДК № 7548 від 16.12.2021. E-mail: office@ranok.com.ua Надруковано у друкарні
«ТРІАДА-ПАК», пров. Сімферопольський, 6, Харків 61052. Свідоцтво суб’єкта видавничої справи
№ 5340 від 15.05.2017. Тел. +38 (057) 712-20-00. Е-mail: triadakniga@ukr.net

rnk.com.ua/107946


Гіпер-, гіпой авітаміноз rnk.com.ua/108469

Для чого потрібно харчуватися? rnk.com.ua/108471

Емоційний інтелект: вирішуємо конфлікти rnk.com.ua/110377

Енергетичний баланс rnk.com.ua/110372

Імплантація зуба rnk.com.ua/108474

Мітоз rnk.com.ua/109378


rnk.com.ua/109978

rnk.com.ua/109797

Робота ферменту rnk.com.ua/107971

Скрайбінг « “Жайворонки” проти “ сов ” » rnk.com.ua/110378





rnk.com.ua/107978


rnk.com.ua/110373




Біологічна роль
в організмі та харчові
джерела вітамінів rnk.com.ua/108468

Дослідження «Порівняння вмісту
вуглекислого газу у вдихуваному та видихуваному повітрі» rnk.com.ua/108461

Завдання «Закономірності кровообігу
людини» rnk.com.ua/108716

Завдання
про первинну та вторинну імунну відповідь rnk.com.ua/110467

Індивідуальне завдання «Аналіз показників дихання» rnk.com.ua/108464

Інформація про способи руху рослин rnk.com.ua/107963

Можливості
зовнішнього
та внутрішнього скелетів rnk.com.ua/108584

(Пре)діабет

STEАM-проєкт

rnk.com.ua/110376


STEАM-проєкт
Таблиця «Енергетичні потреби людини» rnk.com.ua/108472 STEАM-проєкт

Таблиця
«Способи пересування (локомоції)
тварин» rnk.com.ua/107962

rnk.com.ua/108473


крові» rnk.com.ua/109107
засобів» rnk.com.ua/110455


STEАM-проєкт «Створення
підручник для 8 класу закладів загальної середньої освіти
Особливості підручника:
практичний підхід до вивчення предмета
змістовна текстова частина увиразнена яскравим візуальним матеріалом
сучасне оформлення
проєктні
Інтерактивний електронний


